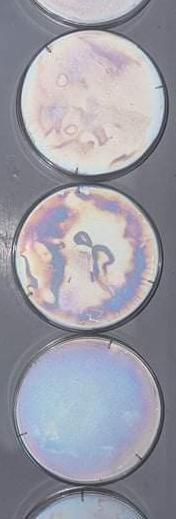
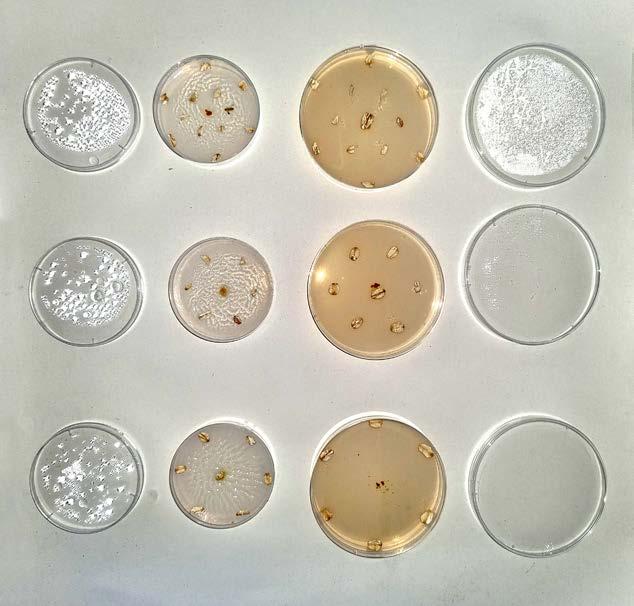
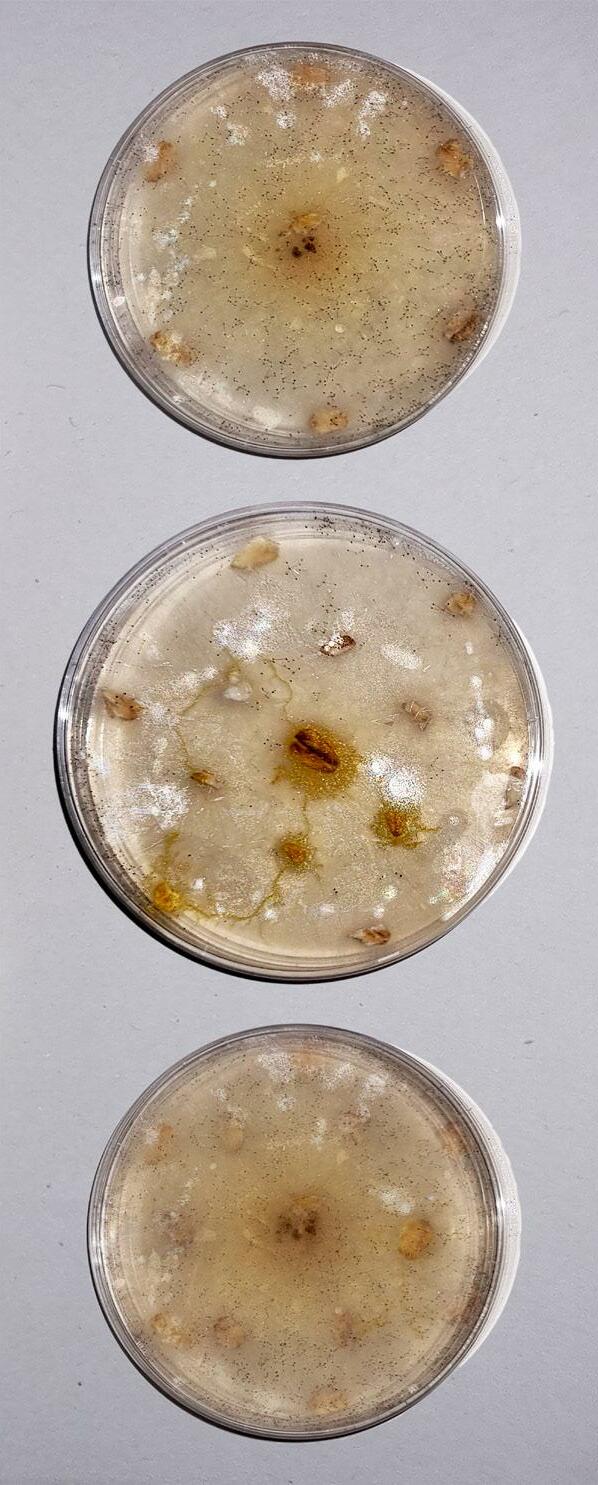
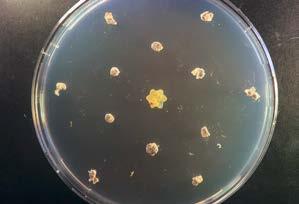
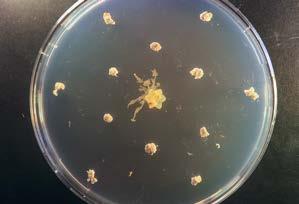
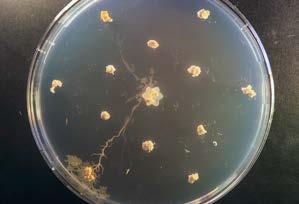
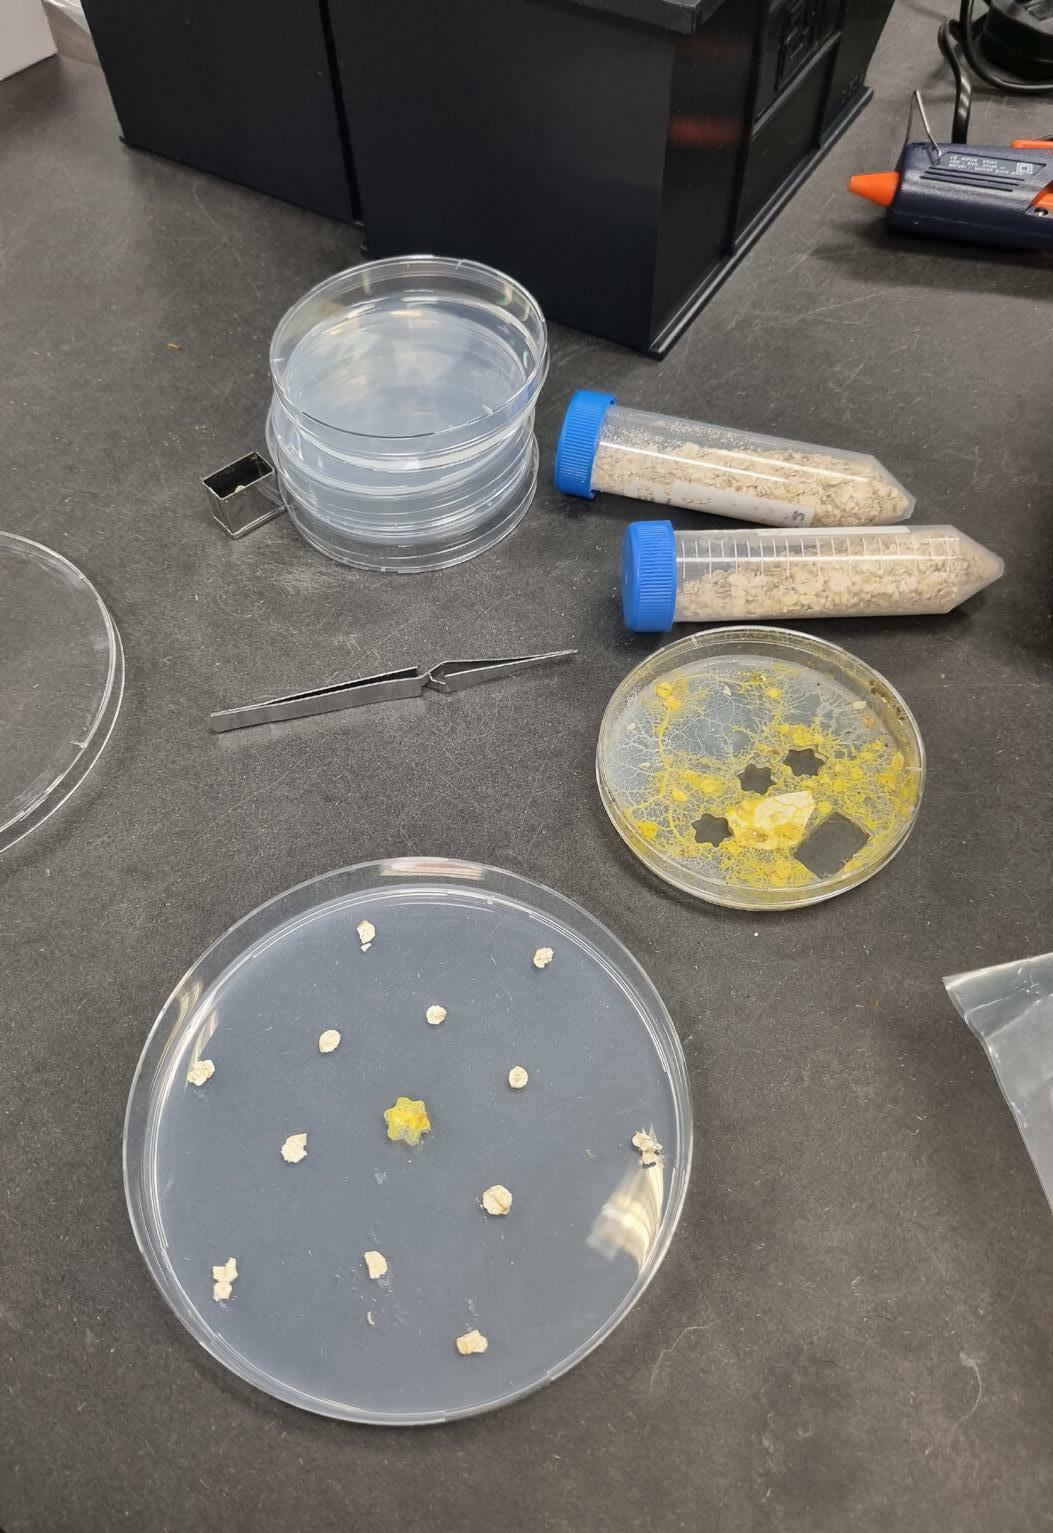
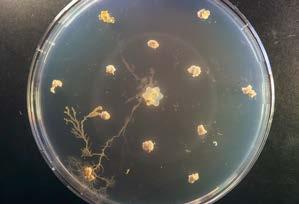
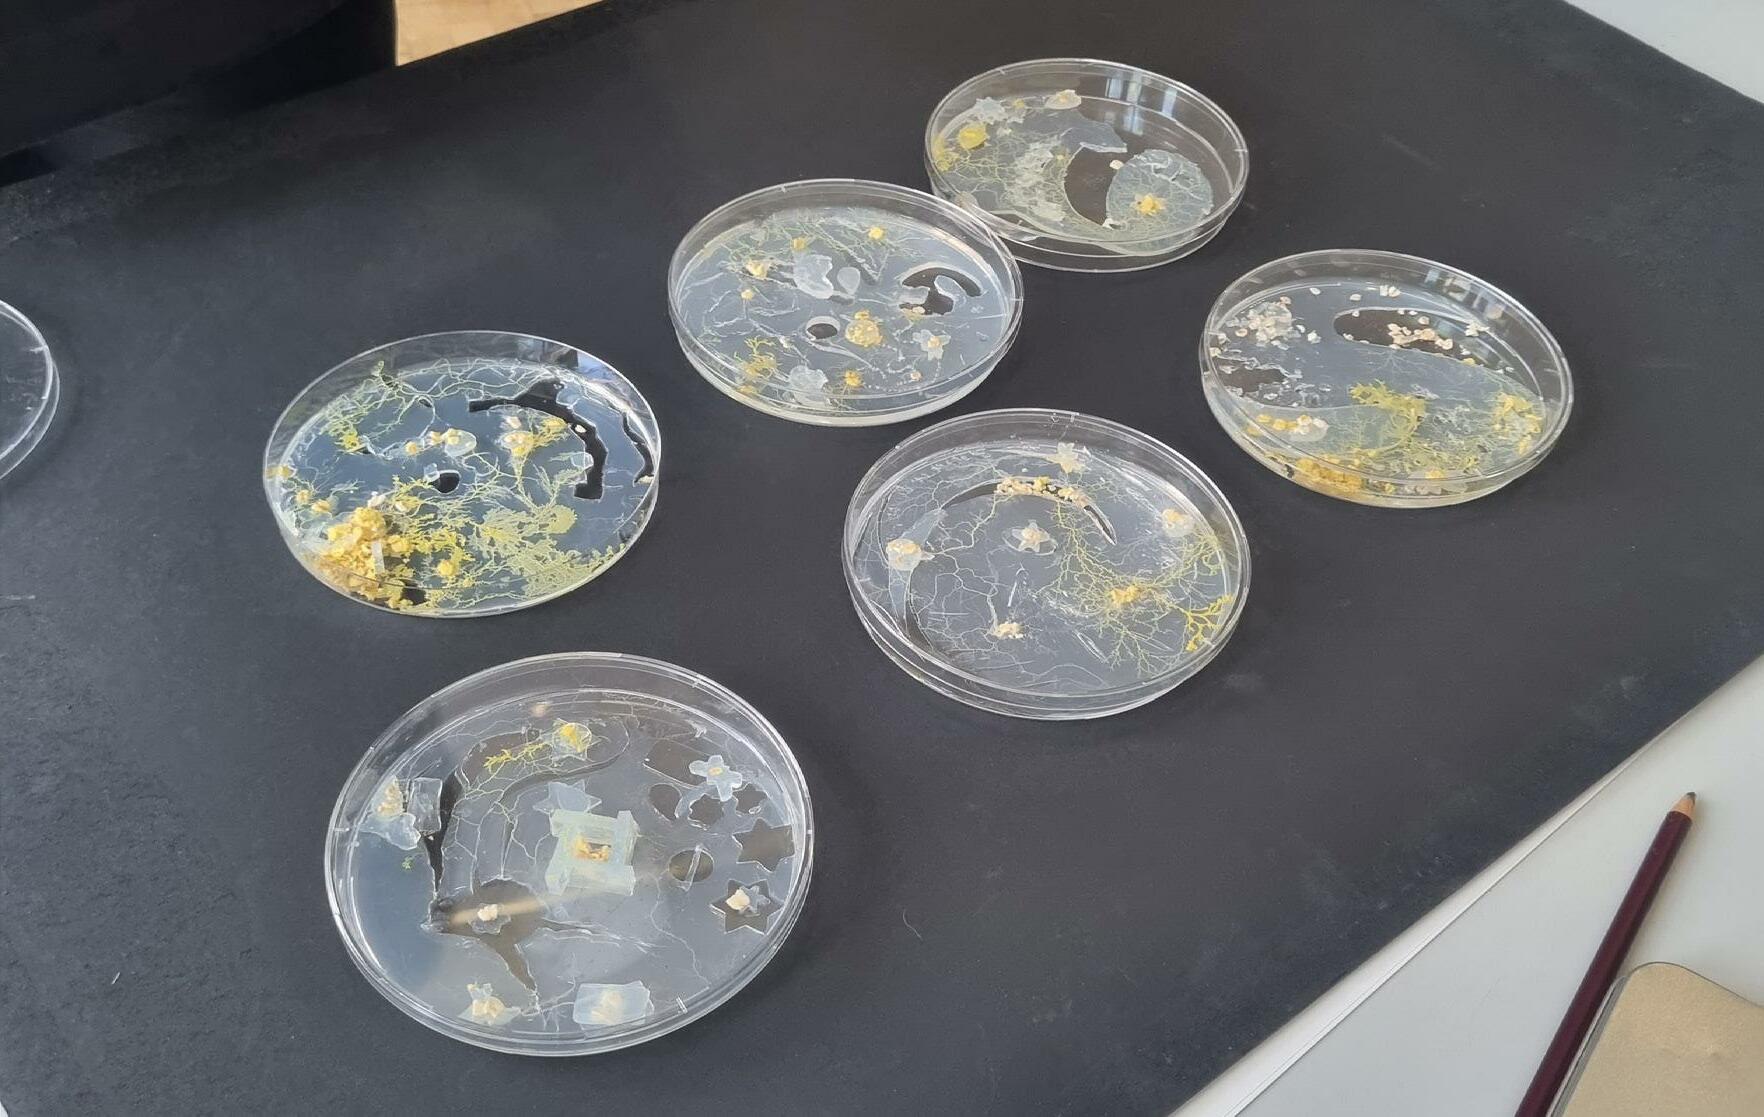

2021/22 /// Portfolio /// 21035859 /// Emma Kemp /// MA ISD 2021/22 /// Portfolio /// 21035859 /// Portfolio /// Emma Kemp /// MA ISD 2021/22
Foreword
The duration of the MA Interior and Spatial Design course has led me on a trajectory towards the culmination of a large body of research coming into fruition as studio practice. This has always been the element of researching formlessness that I have found the most difficult; how do you constrain a philosophy about an inherently chaotic ideal such as formlessness into a tangible output? My experimentation and readings led me to a two-part solution. The first is a series of photograph studies, methodologically categorising L’informe into four categories that I have come to define: Destructive, Mutative, Pervasive and Emergent. These images form the basis of a Typology study, a visual dictionary that aims to introduce the many faces of the formless to the ‘reader’. These book-objects however, also function as performative pieces that not only depict their subject, but embody it. The second part of my practice is the recording of videography of the destruction of these dictionaries, their formless subject reclaiming the housing in which it has been trapped. The final part of my practice sits alongside the resultant film, in the form of a manifesto, further defining the formless, emphasising the need for its adoption amidst our current cultural and political climate, and provoking a potential formless future.


Whilst I have presented previous portfolios chronologically, for the culmination of this past year’s work, I have decided to instead categorise it via the typologies that it depicts. Each of the first quartet of chapters starts with a few words on it’s namesake, then reflects on a few experiments from earlier units that influenced the form that the final book-object took. The chapters then end with the development of these studio outputs and their reclamation by The Formless. The penultimate chapter looks ahead, towards the sharing and dissemination of the work to the wider community, including exhibition, conference, and manifesto. Finally, I attached the Research Record, an extended visual appendix of further research, influence, and work that didn’t quite fit in amongst that of the portfolio.
Context: Entropy & Patchwork
Context: Lunar & Spatial Mutation Typology
Part 02 DESTRUCTIVE Part 03 MUTATIVE Typology
20 28
Pavements
42 52
Contents Staging: Form // Formless 24
PREQUEL Practice Past Work 08 14 Introduction to L’informe 10
Part 01
Part 06 EMERGENT Part 07 RESEARCH RECORD Staging: A Home for Form // Formless Part 04 PERVASIVE Typology 66 72 Part 05 REPRESENTATION & DISSEMINATION Context: Dust & Site Context: Physarum Polycephalum & Making Waves 90 108 For additional research, readings and appendices, please see separate documentation attached. Critical Research Paper Portfolio 126 122 Typology 112 Manifesto Exhibition 144 134
Dissertation
Formlessness and Architecture: How the study of The Formless could reshape an Architect’s approach to Design.

A note on the form of this essay:
projects of artists cited in Highmore, own work and to be so, and not Guide’ becomes a (Highmore, 1999) that can to other fields.

horizontality, the simplest Pollock transferred plane of an artist’s rubbish in “main“Pollock’s work the body, and every moment butts dropped base humanistic formless. Bois revolt, not for (JacksonPollock.org, n.d.)
specifically to provide
3
My study of the formless has demonstrated that the traditional format and methods through which we approach everyday tasks are not necessarily the most effective way of conveying or achieving what we are aiming to do. I hope to demonstrate and attempt to exemplify this by structuring my dissertation in two ways: the formal versus the formless. The formal essay structure follows all the rules of academic writing, whilst the formless demonstrates the true organic process that has allowed the writing to take shape. I hope this provides visual representation of some of the many iterations and added discoveries that occur when writing a dissertation, and shows that there is value in showing this process. In addition, it allows me to be able to physically locate paragraphs that have a strong relation to each other together, when they cannot sit adjacent within the formal essay. It could be interpreted as an integrated appendices or an elaborate footnoting method, however I hope it demonstrates the value of a formless writing approach.
A note on the form of this essay:
My study of the formless has demonstrated that the traditional format and methods through which we approach everyday tasks are not necessarily the most effective way of conveying or achieving what we are aiming to do. I hope to demonstrate and attempt to exemplify this by structuring my dissertation in two ways: the formal versus the formless. The formal essay structure follows all the rules of academic writing, whilst the formless demonstrates the true organic process that has allowed the writing to take shape. I hope this provides visual representation of some of the many iterations and added discoveries that occur when writing a dissertation, and shows that there is value in showing this process. In addition, it allows me to be able to physically locate paragraphs that have a strong relation to each other together, when they cannot sit adjacent within the formal essay. It could be interpreted as an integrated appendices or an elaborate footnoting method, however I hope it demonstrates the value of a formless writing approach.
Form and architecture are two words that are often synonymous with each other; one cannot be without the other. Architects are obsessed with the manipulation, creation and manifestation of form, grasping at any opportunity to exert the maximum control over every element of a design. This embodies the typical approach to design where the form is created as a whole and then filtered down through every element of the building, i.e. top down. Recently, increasing numbers of creators have begun to explore a new approach of working from the bottom up, to a certain extent relinquishing control over the final outcome. This is apparent in many pioneering biological designs, where seemingly organic forms respond to their environment and thereby are partially allowed to shape themselves. This movement towards a bottom up approach could indicate a potential need for a change in design methodology, where the grip of control over the final form is loosened. By considering the antithesis of form, formlessness, and extracting the different elements from this, this essay aims to demonstrate how formlessness could be used to alter an architect’s approach to design.
Abstract
11 Abstract
11
Extracts from my dissertation “Formlessness and Architecture”, where I studied the artistic style of formlessness and proposed how it could be applied to the built environment to create bottom-up, occupant-led design – the opposite of the top-down approach which seems to all too prevalent in design of spaces; where form is prioritised sometimes at the expense of the users, and the designer finds themselves wrestling to exert maximum control over every element of the design.
Extracts from my dissertation “Formlessness and Architecture”, where I studied the artistic style of formlessness and proposed how it could be applied to the built environment to create bottom-up, occupant-led design – the opposite of the top-down approach which seems to all too prevalent in design of spaces; where form is prioritised sometimes at the expense of the users, and the designer finds themselves wrestling to exert maximum control over every element of the design.
Embracing formlessness means we are no longer obsesses with form, encourages the unintentional, what occurs acciden

8
are the successful cities, if any? Are all members of society included in that success?
Where
that The Formepitomised by nature, created diminutive pieces of constructed benefits of relinideals of the celebration of chaBataille’s love for the materials to create Acting like a sopre-programthat has been print complex high-tech yet (Kayser, M & De project to harness materials in an orthat there workshops within the globSanyal, 2015). 5
Extracts from my dissertation, partially demonstrating the ‘formless’ half of the work - The research was key in developing my human-cen-
The formless inserts do not follow the page numbering system, and are not included in the contents. The information included in these inserts relates to information being discussed in the formal essay at the place of their insertion. All information and images used in the formless essay is referenced within the formal bibliography and list of images.
Form and architecture are two words that are often synonymous with each other; one cannot be without the other. Architects are obsessed with the manipulation, creation and manifestation of form, grasping at any opportunity to exert the maximum control over every element of a design. This embodies the typical approach to design where the form is created as a whole and then filtered down through every element of the building, i.e. top down. Recently, increasing numbers of creators have begun to explore a new approach of working from the bottom up, to a certain extent relinquishing control over the final outcome. This is apparent in many pioneering biological designs, where seemingly organic forms respond to their environment and thereby are partially allowed to shape themselves. This movement towards a bottom up approach could indicate a potential need for a change in design methodology, where the grip of control over the final form is loosened. By considering the antithesis of form, formlessness, and extracting the different elements from this, this essay aims to demonstrate how formlessness could be used to alter an architect’s approach to design.
The formless inserts do not follow the page numbering system, and are not included in the contents. The information included in these inserts relates to information being discussed in the formal essay at the place of their insertion. All information and images used in the formless essay is referenced within the formal bibliography and list of images.
PAST WORK
could be themselves design.
could be themselves design.
Ifirst came across the formless during my undergraduate degree in architecture, when I wrote my dissertation on ‘Formlessness and Architecture: How the study of The Formless could reshape an Architect’s approach to design’. Although I attempted to translate the principles I was writing about into my project work, I was unsatisfied with the outcomes, feeling that they did not embody the principles of formlessness, or even that I had fully defined what my personal definition of the formless was. Instead my work tended to identify what I believe to be the key shortcomings in today’s architecture, and give me an introductory understanding of the topic as a whole. Nevertheless, my previous dissertation serves as an important grounding to my work, as a desire to further this research was a key driver in me pursuing my masters. Thus, I have chosen to include it in this portfolio (in full within the research record), for reference, and to give an indication of the background knowledge gained on the topic prior to beginning the MAISD.
9
9
Throughout Unit 1 I have been using each of the sequences to research various areas of The Formless to further my understanding of the topic that I plan to use as a lens through which I will approach research going forward into Unit 2. I will begin by recapping what I have covered this term, then touch on what I envision to do going forward, as well as hopefully introducing the topic as a whole.
Throughout Unit 1 I have been using each of the sequences to research various areas of The Formless to further my understanding of the topic that I plan to use as a lens through which I will approach research going forward into Unit 2. I will begin by recapping what I have covered this term, then touch on what I envision to do going forward, as well as hopefully introducing the topic as a whole. 2
THE FORMLESS: NEW WAVE FUNCTIONALISM
THE FORMLESS: NEW WAVE FUNCTIONALISM
2During my undergrad, I began by considering where architecture today falls short. Climate change and overpopulation are at the forefront of many designer’s minds, yet our cities and projects continue to be driven by economics instead of ethics. I have been continuing my study of the formless as a lens through which to tackle these issues. 3
During my undergrad, I began by considering where architecture today falls short. Climate change and overpopulation are at the forefront of many designer’s minds, yet our cities and projects continue to be driven by economics instead of ethics. I have been continuing my study of the formless as a lens through which to tackle these issues. 3
The formless is a term coined by George Bataille in 1929, intended to celebrate the debased in us all, a reactive movement to what he referred to as ‘high art’. Counterintuitively, the movement was expressed in the works by many popular modernist artists, including Jackson Pollock, which are now held in high regard - to the chagrin of Bataille I’m sure.
The formless is a term coined by George Bataille in 1929, intended to celebrate the debased in us all, a reactive movement to what he referred to as ‘high art’. Counterintuitively, the movement was expressed in the works by many popular modernist artists, including Jackson Pollock, which are now held in high regard - to the chagrin of Bataille I’m sure.



108
1
George Bataille inspecting the cave paintings at Lascaux, Montignac, France.1
108
One: Number 31 by Jackson Pollock, 1950.2
1
George Bataille inspecting the cave paintings at Lascaux, Montignac, France.1
10
One: Number 31 by Jackson Pollock, 1950.2
The formless in relation to architecture is demonstrated in many works of, typically, fictional literature - although it may not be aware of doing so. Rose and Ricciardi also link it to tangible architecture in their Formless Series 01 Manifesto, although I have found very little literature on the topic beyond this. These are the themes I explored in Sequences 1-3.
5The work that led me to the formless, was the study of biomimicry, due to many of the examples of work in this field exhibiting formless traits. In particular, the work of Rachel Armstrong inspired me, with her research in the emerging field of living architecture.



4
1 Gagosian Quarterly, 2018. Bataille's First Glance. [image] Available at: <https://gagosian.com/quarterly/2019/07/03/essay-batailles-first-glance/> [Accessed 19 December 2021]. 2 MoMA, 2021. Jackson Pollock One: Number 31, 1950. [image] Available at: <https://www.moma.org/collection/works/78386> [Accessed 19 December 2021]. 3 AA Bookshop, 2021. Formless: Storefront for Art and Architecture Manifesto Series 01. [image] Available at: <https://aabookshop.net/?wpsc-product=formless-storefront-for-art-and-architecture-manifesto-series-01> [Accessed 19 December 2021]. 4 Watson, P. and Morris, J., 2014. Illustration of what the starship Persephone might look like by Phil Watson & Jon Morris. [image] Available at: <https://www.dezeen.com/2014/05/25/movie-rachel-armstrong-living-architecture-project-persephone/> [Accessed 23 October 2021].
6 A PECHA KUCHA PRESENTATION
Visualisation of the starship Persephone, a living architecture project by Rachel Armstong.4
Formless Series 01 Manifesto by Rose & Ricciardi.3
Throughout Unit 1 I have been using each of the sequences to research various areas of The Formless to further my understanding of the topic that I plan to use as a lens through which I will approach research going forward into Unit 2. I will begin by recapping what I have covered this term, then touch on what I envision to do going forward, as well as hopefully introducing the topic as a whole.
NEW WAVE FUNCTIONALISM
Leading on from studying biological systems, I next looked to natural phenomena for inspiration. When considering dissipative structures as an exhibitor of formless principles, I found that Olafur Eliasson and Fujiko Nakaya were my primary inspiration. In Sequences 4, 5 and beyond, I explored working with clouds, dry ice fog and wax to capture processes in various ways.

During my undergrad, I began by considering where architecture today falls short. Climate change and overpopulation are at the forefront of many designer’s minds, yet our cities and projects continue to be driven by economics instead of ethics. I have been continuing my study of the formless as a lens through which to tackle these issues. 3
Previously, when 7

Both biomimicry and the elemental reaction are processes that respond to their environmentthey have no control over their forms, but they can be beautiful nevertheless.

The formless is a term coined by George Bataille in 1929, intended to celebrate the debased in us all, a reactive movement to what he referred to as ‘high art’. Counterintuitively, the movement was expressed in the works by many popular modernist artists, including Jackson Pollock, which are now held in high regard - to the chagrin of Bataille I’m sure.

110
6
8
Sequence 4, “Dissipative Structures”.
Fujiko Nakaya’s Foggy Forest, Tokyo 1992.1
108
Olafur Eliasson’s ‘Water Pendulum’.2
THE FORMLESS:
1
2
George Bataille inspecting the cave paintings at Lascaux, Montignac, France.1
12
One: Number 31 by Jackson Pollock, 1950.2
9

However this didn’t feel like the solution. It clicked during our last lecture with Ken Wilder that this is functionalism, but a new generation of the previous ethos, hopefully addressing some of the previous movement’s shortcomings. I plan to illustrate these links further through my CRP.
I also aim to situate my work more clearly within this realm during Unit 2, hopefully creating a New Wave of Functionalism through the lens of The Formless. I imagine this to take the form of material experiments, a manifesto for approach to design, and an immersive algorithmic deep AI installation demonstrating formless principles as a new concept for creating or growing a formless city. 1

2016. Home designed by Alejandro Aravena in Iquique, Chile provided ‘half a good house’, with the structure to be expanded by the residents themselves.. [image] Available at: <https://www.theguardian.com/artanddesign/2016/apr/10/architect-alejandro-aravena-pritzker-prize-elemental-housing-iquique-constitucion-tsunami-defences> [Accessed 19 December 2021].

4 Raff, C., 2021. algae experiment II. [image] Available at: <https://carolynraff.de/algae-experiment-ii> [Accessed 19 December 2021].

10
Available
<https://thefinchandpea.com/2013/04/03/the-art-of-science-fujiko-nakaya-creates-an-atmosphere/> [Accessed 19 December 2021].
[image] Available at: <http://www.redbrickartmuseum.org/exhibitions/water-pendulum-exhibition-of-red-brick-art-museums-collec
19
2021].
C.,
Ogawa, S., 2013. Fujiko Nakaya’s Foggy Forest, Tokyo 1992.. [image]
at:
2 Red Brick Art Museum, 2016. Water Pendulum – Exhibition of Red Brick Art Museum’s collection.
tion/?lang=en> [Accessed
December
3 Palma,
Sequence 5, “Mountainscape”.
Example of Aravena’s Half House.3
Carolyn Raff, ‘Algae Experiment II’.4
OUTPUTS
S










W A L K IN G P RA C T ICE STAGE 01 OF STUDIO
HOW WALKING AS PRACTICE HAS INFLUENCED MY EXPLORATION OF L’INFORME








“A socially engaged, public performance practice is: the site-specific embodiment of urgent social issues ... through considered human gesture, such as conscious walking, ... ethically made and generously shared with a community ... as a form of diagnostic, collective, poetic portrait, ... freely offered for aesthetic appreciation and meaningful reflection, ... ultimately seeking a socially transforrnative, cultural experience.”1
Walking as practice has had a huge influence on my work throughout the year. Introduced to the course during Unit 1’s Sequence 3, it has also held importance in my own practice prior to this, via observation of rapid regeneration and global homogenisation that influence my critique with the cost of control within today’s architectural trends. Over the duration of the course, I have relied upon it heavily, giving context and site specificity when considering more philosophical concerns in relation to L’informe. In a practical sense, it has provided me with a key practice that has enabled me to produce my studio outputs at the culmination of this year: an extended Typology study. By walking the city in which I live, London, and observing it with criticality, I have been able to identify The Formless almost everywhere I look. My records of this observation, the series of typological photo books, has become a visual dictionary that helps define and categorise an inherently boundless topic such as formlessness.
step outside. have purpose. wander. look critically. see the unseen. observe.
sketch. audio. film. write. photograph. memorise. return. repeat.
criticise. interrogate. cross-reference. refine your records. review and reflect on your findings.

OBSERVE 01
02 RECORD
03
REFLECT
1Pujol, E. (2018) “A Working Definition,” in Walking art practice: Reflections on socially engaged paths. Triarchy Press, p. 16.
THE BOOK as SPATIAL

Although somewhat prevalent in the art world, identified in the works of Pollock, Dubuffet and Warhol, L’informe is more commonly found and defined in books. The book as an object is often overlooked, seen as a purveyor of information leading to more tangible creations. Its usefulness as an object within its own right, in the realms of interiors at least, seems bound to that of a prop; a coffee table book carefully strewn across a surface, the colour of its cover considered as part of a wider set design scheme. Even within the art world the book somehow seems to hold less value than a typical plane or installation; at a recent exhibition of Louise Bourgeois, despite the titular piece, ‘The Woven Child’ being in the form of a book, it was displayed imprisoned within a frame, converting the book-object’s inherent movement, tactility and three dimensionality into a more easily digestible display piece. When I visited, although crowded, no one stood in front of this work, instead preferring the more dramatic three-dimensional pieces.

In contrast, when exploring artist’s books in the V&A Museum’s library, I was simultaneously awestruck and horrified when, after requesting to view a selection of items from their special collection of artists’ books, these original artworks were placed in front of me to handle. I found this presented a dilemma, as although it was greatly enjoyable to be able to interact with these items on a first hand basis, it highlighted the difference in perceived value between these items and their canvas counterparts. La Lunette Farcie, by Jean Dubuffet stood out in particular; an original work of a well respected and recognised artist, the tome still in the form the artist intended, open for the public to handle at will? It felt akin to walking into the National Gallery and stroking a Turner to get a feel of the paint, without retribution.
However, although not perhaps as mainstream as other forms
PRACTICE
20
16
04 19 62
of artwork or design, there have been many examples of the book in its own right being recognised. The V&A exhibition, ‘Blood on Paper: The Art of the Book’, brought together a range of Artists’ books from a variety of disciplines. Although some were more traditional representations of work, collections of photography for example, in a marginally more considered binding than the norm, those whose “work is the concrete realization of an idea in a form which is inseparable from that realization” began to exhibit elements of formlessness via their embodiment of their subject over aestheticism. Those that could be thought of in this way tended to embody their artistic practice within the binding space of the book. Cai Guo-Qiang’s ‘Danger Book: Suicide Fireworks’ for example surpassed aestheticism in the design of his book, instead embodying the uncontrolled nature of his fiery explorations within the book itself, the pages acting as both site and record for his work. This reflects the opinion of Macken who wrote “Artists’ books offer the opportunity for the page not merely to hold a reproduced image on its surface, but rather the page may be seen as an image”. My study of The Formless has led me to explore methods of conveying theoretical concepts and meaning outside the bounds of traditional architectural representation. By attempting to represent such a broad reaching concept, I have found that the confines of drawing and model making fall short. Further to this, I have come to understand that models and drawings in some ways exclude the viewer; they convey interiority without offering the experience. In contrast a book, through “The act of turning the pages or making the volume becomes a physical sculptural element […]. The content of these books becomes spatialized through their structure, and meaning is read through the manipulation of pages.” In addition, “the book offers the opportunity for random and multi-directional reading”, where, when all elements are combined to form a provocative representation of the concept they are intending to convey, they not only invite the user to become part of the theory, they also offer flexibility in interpretation, a trait which I believe is imperative to encouraging accessibility when introducing L’Informe to the wider design community.
 Foster, E. and Watson, R. (2008) Blood on Paper. London: Ivory Press.
Drucker, J. (1994) The Century of Artists’ Books. 2nd ed. New York: Granary Books Inc, p.181.
Foster, E. and Watson, R. (2008) Blood on Paper. London: Ivory Press.
Drucker, J. (1994) The Century of Artists’ Books. 2nd ed. New York: Granary Books Inc, p.181.
20 08 17
Macken, M. (2018) Binding space: the book as spatial practice. London: Routledge, Taylor and Francis Group, pp. 29, 95.
DESTRUCTIVE








DISSIPATIVE STRUCTURES

“Adissipative structure requires that a portion of the energy flowing through it be used to maintain the far from equilibrium, stable, steady state, while the entropy of the universe increases at a more rapid rate than would occur if the dissipative structure did not exist.” 1
& ENTROPY
Prototype title: ‘Nephology’. Conceptualisation and experimentation with movement and fragmentation.


Following my research into environmental processes, and inspired by the work of Olafur Eliasson alongside Diller Scofidio & Renfro’s The Blur Building, I transitioned into examining environmental processes as opposed to biological systems. In particular I began by looking at the formation and dissolution of clouds, as an example of a dissipative structure that exhibits both formless and entropic traits.
I aimed to model a physical manifestation of these processes, by filming the formation of clouds, which is then projected onto multiple layers of
muslin. In the darkened room I also created air flow, adding movement to the fabric that was hosting the visual representation, in the hopes to capture the ephemeral nature of the process, the constant flux. This transience is also shown as the image fragments as it passes through each layer of fabric, distorting and once again dissolving. The temporality of the model, a prototypical installation, also demonstrates the principles of entropy - from nothing, into being, into nothingness again. I captured this process both on camera and film, as shown in images right and overleaf.
1
1
of
Elsevier, 2019, Pages 1-3. 2Oxford English Dictionary, Online, 2021, Access Date: 28th October 2021.
“A lack of order or predictability; gradual decline into disorder.” 2
Yaşar Demirel, Vincent Gerbaud, Chapter
- Fundamentals
Equilibrium Thermodynamics, Editor(s): Yaşar Demirel, Vincent Gerbaud, Nonequilibrium Thermodynamics (Fourth Edition),



 3 PATCHWORK PAVEMENTS
3 PATCHWORK PAVEMENTS

When walking the streets of Stockwell I initially wanted to document the differences in housing I encountered - the historic, multi-million pound Georgian and Victorian properties in adjacent contrast to the myriad of public sector housing estates. Whilst the privately owned homes are well maintained yet silent, communities have formed within the public places of the estates, creating hives of activity amid space that has fallen victim to tragedy of the commons.
I began to think about how a bottom-up approach to design of public owned housing estates could work; handing ownership of land back to its users and allowing residents to build as they see fit. An allotment-inspired form of self build architecture, and when considering what this could look like I return to considering the pavements as I walk.
34
22
As designers we value the vertical architecture that forms our cities yet below our feet are patchworked histories displaying the layers of time and delineations of ownership. Relinquishing aesthetics, patched up over time, specified to fit a variety of briefs and needs, the prioritisation of function over form. A thin skin that allows Londoners to wander, whilst concealing the march of utilities and transport hidden in the dark earth. Both a defining line for a commuter and an unconstrained home for the lost. The ground below our feet is both formless and formed, abiding by different laws to the planning constraining our buildings. What would a vertical London construction be if it were built in the same way; slave to function and repair and addition and wear - indiscriminate public space.


35
Scan to view film. 23
CONTROL: FORM // FORMLESS
To begin my studio practice of Unit 3, I began with organising the photographs I had been collecting over the past year, and identifying some additional site visits required to complete a comprehensive collection of images that represented my understanding of L’informe. Some of these additional visits included a trip underneath Moorgate underground station, to the abandoned tunnels below, to Battersea Arts Centre which was destroyed in a fire and still holds many of the scars from this event, and to Kings Cross station, an area of rapid redevelopment over recent years. These spaces have all had massive redevelopment by well known architectural practices, yet when you
study the plans and renders published by these designers and new articles, and contrast them with the lived experience of these spaces, the contrast is undeniable. To reflect this, and provide commentary on a key theme of my formless research (that we never have true control over the space we create, and indeed we should not), I began the culmination of my work with a staging exercise. I sourced the floorplans of these spaces, and emulated them through tracing paper, which was then overlaid across my own photographs that I found during my visits. The resultant palimpsests show at once the vision and the reality, the formed and the formless, and create the first step in the realisation of the theory into practice of Unit 3.
24





The Destructive is categorised by decay; the passage of time, returning to the natural order, and human intervention alike. Pebbles along the shores of the Thames are made of the city; like



dust, they are made of the architectures both new and old alike, remnants of human activity. All that starts off as new, pristine, unbroken eventually falls victim to
 Cracks showing through the white tile
Cigarette butt amidst a ecological reserve
Parts of the city, part of the beach. Greenwich
Cracks showing through the white tile
Cigarette butt amidst a ecological reserve
Parts of the city, part of the beach. Greenwich
DESTRUCTIVE // TYPOLOGY SW10 E8 NC1 30
the destruction of time. Cracks appear, and the solid materiality of the most stoic objects eventually start to crumble. Sometimes


these appear from the more destructive persons amongst our populations, others are just indicators of age. Often these examples of L’informe are set in

juxtaposition against the new and shiny, reminders that our control over our designs is only ever temporary. All architecture and industry will eventually rust into dust, an entropic return to the chaos from which we came.

following a fire
Charred plaster
Cracks in the skin of the city
Deterioration of industry
Rusting amidst the crops
EC2R SW11 MNE
To construct the destructive typology study I began by selecting the


PRINT
REPRESENTATION TEST
most appropriate photos from the collection taken over the past year. When selecting these photos, I considered how well they represent the formless characteristic they representDestructive. The resultant photographs were

D EV E LO P // D E ST R OY
slightly more apparently random than some of the other collections, tied together by the cracks, rust and dust that appear in most. They show the decay of time, or the destruction caused by human anarchy, and to reflect and embody this characteristic I planned to burn the book, page by page. To achieve this, I burn

DESTRUCTIVE //
32
a variety of weights of papers to assess the best burn speed. I planned to have them burn slowly enough so that the entire book wouldn’t go up in flames instantly, but fast enough to achieve a reasonable burn on each page. Surprisingly, many test pages didn’t catch light at all, rather just the edges became singed. For the images, I printed them on classic photo paper that melts and curls upon burning.
BU RN STITCH
For the binding, the pages need to lay flat, and not be glued as I was concerned about fumes when burning.




ASSEM BLE
As the paper was a 120gsm watercolour, it was able to support minimalist stitching, so I sewed each page individually with a simple loop. This counterbalanced the more decorative fixings on the photographs, for which I used a simple paper corner, designed to burn smoothly. The sewn text block was then affixed to the cover, which I wrapped in a soft canvas printed with one of my favourite typology photographs, an image of cracked tiles disintegrating off the wall, with the title printed in small white lettering in the top left corner of the front cover.

33
When considering the presentation of the typology series, I feel that they would function best as performative art pieces, offering an accessible and engaging way into the topic of formlessness that would spark conversation amongst the wider community. However due to limitations in the scope and scale of this project, it has not been achievable to perform these deformations on a public stage. Instead, I have chosen to film the desecration of the book objects, with the intention of documenting the act for presentation in a public forum - the conference at the culmination of the course. For some books, the burning of the destructive typology in particular, safety reasons confined me to perform the burning in a private setting, with as many safety precautions on hand as necessary.

DESTRUCTIVE // REALISATION
34
ST ART












E ND 35
When undertaking the burning of the Destructive typology, my main concern was for safety. Ideally, I would repeat the performance in a public setting, with appropriate safety measures in place that would allow me to continue the performance to a greater degree. As it was, I had water mist on hand to prevent the blaze from getting out of hand, and you can see my attempt to turn the


DESTRUCTIVE // REALISATION 36

pages and control the fire throughout the video. The nature of the fire meant that I was unable to control the burn of the book, so the resultant burn pattern and remnants was largely representative of formless action, yet my fear of the fire and attempt to control it, and turn the pages work in conflict to this process. Many of the photographs are mutated, partially destroyed yet their contents are still recognisable. By practising acceptance of the outcome, without holding onto any preconceived notions of what these could be, I find myself enjoying this new aesthetic, contrasted by my own fear attempt to control during the burning process. This acted as a microcosm for formless action in the wider world; although often we fear it and attempt to exert control, it comes anyway, sometimes changing our environment in ways we could not expect but are in fact, improved.


DESTRUCTIVE // REFLECTION 38










MUTATIVE
When developing my thinking through model making from the study of dissipative structures and entropy, I found myself considering the opposite also - instead of capturing a process in constant flux, how could I freeze a process to an instant and create a static representation of a single moment of movement. Perhaps inspired by looking in depth at Eliason’s work, in particular his ‘Split Second Home’ series, or his glacial pavilions, where he ‘freezes’ water, both metaphorically and literally (firstly by capturing water droplets with strobe lighting, so they appear static in that instant of brightness, and secondly by creating ice sculptures by placing dripping pipes outside in the Norwegian winter nights). For my own work, I chose to work with wax, due to its low melting and solidifying points, familiarity and access.


62
4 LUNAR
42




WAX EXPERIMENT



70
44
With influence from Nakaya’s work with fog, I was able to source some dry ice pellets and was curious to repeat my wax experiment with another element involved. Before, the outputs were the result of the mixing of the hot wax and cool water; this time the wax met a third and fourth element from the dry ice and the steam it produces in contact with water. The resultant formations were more dynamic than in experiment

01, with the dry ice gas extruding tunnels and turrets through the wax, creating more interesting landscapes. Similarly to last time however, the wax froze solid, creating a perfect freeze frame of the instant the liquids at various temperatures met.

71
02
45
Scan to view clip of experiment.




72 46
My last experiment was influenced more by Pollock (and general curiosity). With a scattered bedding of dry ice left, I poured the remaining molten wax over the top, expecting it to react comparably with its volatile reaction to water. The effect was much more subdued however, and I found the most interesting part of the study was when watching the ice slowly freeze the wax, the wax in turn cracking sporadically. To me it was reminiscent of Jackson Pollock’s poured and drip paintings, if combined with Eliason’s love of playing with freezing elements.
WAX EXPERIMENT 03
73
47
Scan to view clip of experiment.
Inspired by the work of Eliasson and, more recently, Nakaya, I became interested in the movement of fog, mist and clouds, and how their migration could change a space. Inspired by the fluctuating installation by Yi at the Tate Modern, and needing to choose a site that allowed people to move throughout a space freely, unimpeded or affected by landscaping such as pavements, seating or fixed sights, I situated my work in the Turbine Hall. The large space can be viewed from the bridge connecting the Natalie Bell and Blatnavik Buildings, the perfect outlook for observing the flow and movement of people below.

76 5 INITIAL
RESPONSE
48
Mapping the locations of those gathered in the Turbine Hall of the Tate Modern, photographed 31st October 2021 at 2:51pm.




90 1234
One photograph, low density mapping.
One photograph, experimenting with frame, perpendicular air flow, fabric across model and dry ice as part of physical mapping.
Return to site, map over time. Layered images and high density mapping.
Collection and dissipation within a constraint, top view and perspective view.
50
Above, clips from the film demonstrating the fog moving perpendicularly across the model. Click on the link to the right to view the film examining this experiment in more detail.
The ‘results’ from the experiment are not clear cut; I found this to be an interesting experiment in applying premises from Eliasson and Nakya’s work to my own - certainly expanding my understanding on the formation and movement of dissipative structures (in particular dry ice and its properties). This in itself is valuable as dry ice fog is one of the more readily available materials to me when investigating and demonstrating dissipative structures as a whole, and will be valuable to take going forward should my research require this in the future.
I also found elements to be interesting outside of my intended area of research; the mountainous forms the heat map evoked, the plasticine almost transforming into rough hewn stone, a miniature landscape created in the living room, myself playing God sending weather patterns across the topography I created. In the interplay of the light ,and consequently, the shadows cast by the roiling fog I also found interest; both controlled by me and uncontrollable - can the formless within tight confines such as these really be formless?
The ‘results’ from the experiment are not clear cut; I found this to be an interesting experiment in applying premises from Eliasson and Nakya’s work to my own - certainly expanding my understanding on the formation and movement of dissipative structures (in particular dry ice and its properties). This in itself is valuable as dry ice fog is one of the more readily available materials to me when investigating and demonstrating dissipative structures as a whole, and will be valuable to take going forward should my research require this in the future.


I also found elements to be interesting outside of my intended area of research; the mountainous forms the heat map evoked, the plasticine almost transforming into rough hewn stone, a miniature landscape created in the living room, myself playing God sending weather patterns across the topography I created. In the interplay of the light ,and consequently, the shadows cast by the roiling fog I also found interest; both controlled by me and uncontrollable - can the formless within tight confines such as these really be formless?
Lastly I must also consider the limits of the experiment. In considering an empty space, I had hoped that the movements of people within could be considered ‘formless’, but in light of more thought and reading, I am now more inclined to link this more closely with chaos theory and conversely, organic patterns. The effect of the installation by Anicka Yi must also be taken into consideration - although arguably formless in and of itself - it would have an effect on the positioning of the visitor below. It is fortunate however that the installation being shown at the time of my experiment and visits was as formless as it was, having less of an impact on visitors than a static installation, however potentially I created a heat map of the positioning of the aerobes and consequently their observers, rather than the people themselves? Further thought is needed.
Lastly I must also consider the limits of the experiment. In considering an empty space, I had hoped that the movements of people within could be considered ‘formless’, but in light of more thought and reading, I am now more inclined to link this more closely with chaos theory and conversely, organic patterns. The effect of the installation by Anicka Yi must also be taken into consideration - although arguably formless in and of itself - it would have an effect on the positioning of the visitor below. It is fortunate however that the installation being shown at the time of my experiment and visits was as formless as it was, having less of an impact on visitors than a static installation, however potentially I created a heat map of the positioning of the aerobes and consequently their observers, rather than the people themselves?
591 5
Air flow across model perpendicular, top view and perspective view.
Scan to view film.
Air flow across model perpendicular, top view and perspective view.
51
Scan to view film.


the bowels of London. The permanent residence of vermin, and transient space of liminality for those that call London home and tourists alike, the network is constantly undergoing change (as the recent opening of the Elizabeth line
When collecting images of The Formless, I decided to seek out abandoned spaces, or those that had undergone rapid change. Living in London, I realised I had a multitude of these



shows), yet it is also in a constant state of decay. For every sparkling new station, there is balance in one that shows the wear and tear of decades of use, water damage and dust. One station where
spaces underneath my feet, in the web of underground tube networks that are synonymous with the city. Back when undertaking sequence 3 during Unit 1, I explored the notion of the pavement as the skin of a city; if this is the case, then the underground network must be
 London Underground’s Stockwell Station, tube platform wall
Wall in Battersea Arts Centre, showing fire damage & construction traces
Ex-Public analysis & sanitary inspectors office, Battersea
London Underground’s Stockwell Station, tube platform wall
Wall in Battersea Arts Centre, showing fire damage & construction traces
Ex-Public analysis & sanitary inspectors office, Battersea
SW11
Lamp post outside The British Library, Kings Cross
MUTATE // TYPOLOGY
you are able to access the disused tunnels below is Moorgate, where I explored the abandoned tunnels that were used as air raid shelters during the war. Now closed to the general
public, these spaces hang in limbo - the tattered posters of companies that have long since ceased trading still are visible beneath a layer of grime. Perhaps it




is the constant renewal of the London Underground network that meant, whilst sorting through and categorising the images of L’informe that I had captured, I found myself sorting many of these images into the section for mutation. The others all also show examples of human driven change, sometimes
intentional, others not, but often caused by many hands, not just one. The result is a patchworking of the architecture’s history, beautiful in some ways, but all just traces of what each user intended, with no one final outcome over which any one person had full control over.
Remnants of advertisement in disused London Underground pedestrian tunnel
Old signage for ‘Lifts’ in disused London Underground tunnel
Graffiti in disused London Underground tunnel
EC2R
Old signage at Moorgate station, London
Inspired by Jean Dubuffet’s La Lunette Farcie, I decided to create the mutate typology book as a series of unbound pages, intended to invite interaction and change from each user. I began by collating the images of L’informe into a collection, then editing this down to a series of 21 final images, each

considered for their value and efficacy in representing The Formless. I edited these images in Photoshop, cropping and adjusting them to create a uniform finish, whilst also best representing the subject. I then had these printed onto single sided fine art quality paper. I printed two batches, one in a sepia tone, and one in full colour. The sepia tone was intended to add uniformity to the collection, however upon reflection
I decided to go ahead with the full colour version, which reflected and enhanced the apparently random nature of the Mutate’s typology. I cropped each page by hand, tearing the paper along a metal rule, creating an uneven textured finish that revealed


MUTATE // REPRESENTATION
56
the construction filaments of the paper itself. I hoped that this first intervention might encourage users to engage more heavily when interacting with the book.



To bind the book, I had one of my favourite images (of a fire damaged and heavily replastered piece of old stone still visible in Battersea Arts Centre), printed on soft canvas fabric, the title of the book
‘Mutate’ printed in small white lettering to be position in the top left hand corner of the front cover. I wrapped this material around the baseboards forming the cover, then fixed the internal canvas holdings and jute ribbon to the cover with rust-coloured thread. Once assembled the book ties shut, holding all the internal loose leaves securely.


MUTATE // REALISATION

 Table set up on day of filming, complete with signage, arts supplies and thank you snacks!
Table set up on day of filming, complete with signage, arts supplies and thank you snacks!
59
Chatting with a participant about The Formless, and the Mutative Typology
The day of filming the Mutate typology study realisation, I set up a table in the lobby of Camberwell College, with signage briefly explaining the project and asking for people’s help. I asked those who were interested in the work, to change the book in any way they liked; there were no rules, you are able to be as restrained or destructive as you like. On a practical note, I also offered free snacks to those who helped as a thank you. Even whilst I was setting up my camera, people were interested and wanted to have a go, so progress started quickly. Poetically, the first contributor drew a butterfly over the first page - the iconic symbol of transformation - perhaps influenced by the simple lettering of ‘Mutate’ printed on the inside front cover. Over the course of 3.5 hours, over 50 people came and became ‘users’ of the work, contributing in a variety of ways. Some doodled, illustrated or wrote, others cut, stuck and glued, making new things out of the pages. Some responded to the images, and added obviously relevant additions, others were random. Each provided a moment of introspection for myself; was this a change I was happy with? Although sometimes yes, some of the more destructive mutations almost hurt to witness, provided an exemplar of why architects and designers try to hold so tightly onto their control over the use of their designs; over time they become almost like our children, to change them, to say that our vision was wrong is like a personal slight to our own tastes. However by the end, the book was changed, permanently, in a way I could never have envisioned. The point of reflection is not whether it is now ‘better’ than it was before, but rather a personal one; that people were invariably interested in the topic and wanted to find a way in. This was revelatory as throughout the course I have struggled with how to make such an intangible subject accessible and practical. This participation from the students, staff and visitors of the university shone a light on a way to move The Formless forwards into a more visible realm.
MUTATE // REALISATION Scan for full video
START END












61

MUTATE // REFLECTION
The final outcome from the Mutative study is the remnants of the book post-change from members of the community at UAL. The experiment started with a simple illustration of a butterfly, the symbolic patron of change, perhaps influenced by the word ‘Mutate’ printed on the front page. What followed was similarly restrained, with contributions at first limited to restrained doodles. However as the course of the experiment progressed, people started to become more destructive. This started with some small tears, progressing to aggressive cuts as people built on what those before them had done. At the peak of the video, the destruction is at its heaviest, with almost all the pages destroyed in some way, completely mutated from their original form. It was at this stage that I thought that the experiment became reminiscent of Yoko Ono’s 1964 performance art ‘Cut Piece’, where member of the public cut away her clothes, emboldening each other to take more, culminating in an almost frightening place as a commentary on the darker tendencies running through our society. Towards the end of the video however, when faced with the brutalised pages, instead of more destruction, participants started to repair the book, reattaching pages in new configurations, glueing and taping fragments back together. Although a reach, could this be a microcosmic metaphor for the state of current society - where along this trajectory do we currently sit? The final outcome is a complete mutation of its original form, altered in a way I could not possibly have foreseen. My plans to replace stolen pages with greyscale versions was not needed, however I believe repeated the experiment in other locations, or at different times could produce an infinitely large number of alternative outcomes.






PERVASIVE
When considering current debate surrounding L’informe, an active proponent is Teresa Stoppani, who utilises it as an instigator for her research into Architectural Dust. Unlike, or similarly to (depending on your perspective) Philip Pullman’s Dust in ‘The Northern Lights’, Stoppani’s dust is at once referring to physical dust, and a more immaterial, transformative action-potential; dust is formless and pervasive, apparent in both used and disused architecture. In her recent lecture ‘Dustings’1 Stoppani sets out how she (and I)


defines dust as formless, and goes on to detail the ways in which dust deconstructs of deforms architecture, including; It is ignored, removed or feared; It is made of us and of the architecture around us; It interferes with architecture; it seeps into it and unsettles and disrupts the order; It challenges and breaks structural and temporal stability; It adds and expands the definitions of form; It indicates a shadow of the ‘whole’, it suggests the fragmenta -

THE WORK OF TERESA STOPPANI EH .SSELMROF / /


Ignored. Removed.
Heide Fasnacht, New Frontier, 2015, coloured pencil on paper, 1016 x 1524mm, Courtesy of the artist and Kent Fine Art, New York.
1 Jeff Koons, New Hoover Deluxe Shampoo Polishers, New Hoover Quik-Broom, New Shelton Wet/Dry 5 Gallon, New Shelton Wet/Dry 10 Gallon Tripledecker, 1981-1987. Three Hoover Deluxe Shampoo-Polishers, one Quik-Broom, one Shelton Wet/Dry 5 Gallon, one Shelton Wet/Dry 10 Gallon, acrylic, fluorescent lights, (231.1 x 137.2 x 71.1 cm (91 x 54 x 28 inches)
2 Man Ray, “Breeding of Dust”, 1920. Detail of the large glass by Marcel Duchamp
3 Richard Hamilton, “Just what is it that makes today’s homes so different, so appealing?”, 1956, 26 × 25 cm, collage su carta, collezione George Zundel, Kunsthalle, Tubinga, Germany 4de Correggio, A., 1531-1532. Danae. [oil on canvas]. Online image available at: <https://galleriaborghese.beniculturali.it/en/opere/danae/>.
Stoppani references the work of Cornelia Parker within one of her lectures on Dust, whose work centres around taking typical forms, processing them through a series of destructions, then reassembling the wreckage. Parker says about her work: “I resurrect things that have been killed off … my work is all about the potential of materialseven when it looks like they’ve lost all possibilities” . 3 Shown here ‘Mass (Colder Darker Matter), 1997, Cornelia Parker. 4
ARCHITECTU R LA &TSUD HT
Made of us & architecture. Breaks structural & temporal stability. Adds & expands the definition of form. Indicates the shadow of a ‘whole’; fragmentation of an unbroken object; at once both the fragment and the fragmented.

tion of an unbroken object; as once both the fragment and the fragmented.
“When does a building become a building? And when does a building cease to be a building? Is the drawing of its ruin an architectural drawing—that is, can an architectural drawing release rather than determine form?”2 As Stoppani posits here, the question of when a building become and
stops being ‘a building’ is not as black and white as it may appear. In the paper she wrote for ‘Drawing is/not Building’, she argues that as a building does not become a building at completion of its construction, nor does it cease to be when it is in ruins, then by extension the very visualisation (drawing) of the building is what brings it into being. She goes on to link this thinkpiece to her extensive work on architecture dust (eponymous for this page), along with the ties
to Cornelia Parkers work: “Implosion applies explosive force to release the energy that is embedded in the building; it releases matter from the form imposed on it by design … It controls the sequence of the process, but not the details of its formal outcome.” In this way her work investigates how the shape of a building currently in existence both has form, but also always has the action potential of the formless, at every stage of its lifetimefrom conception to destruction.
Continue overleaf for:
DUST AND THE INTERIOR

Feared. Interferes. Unsettles. Disrupts.
1 Stoppani, T., 2022. Dustings [lecture], Online, coordinated by Material Spatial Practices Programme Director, Adrian Friend.
2 Stoppani, T, writing for Snooks, R., Treadwell, S. and Twose, S., 2016. Drawing Is/Not Building. Wellington, New Zealand: Milne Print, pp.54-55, 80-81.
3 Parker, C., 2022. Cornelia Parker Art, Bio, Ideas. [online] The Art Story. Available at:
<https://www.theartstory.org/artist/parker-cornelia/#:~:text=%22I%20resurrect%20things%20that%20have,’ve%20lost%20
all%20possibilities.%22>.
4Womens Art, 2018. Mass (Colder Darker Matter), 1997, Cornelia Parker, English sculptor and installation artist #womensart. [image] Available at:
<https://twitter.com/womensart1/status/1048100082212659200>.
Whilst considering the pervasive nature of The Formless, I began seeking examples of it within highly designed spaces, that would be considered the opposite of formless. One such example of these spaces are the number of large developments currently under construction in rapidly gentrifying areas of London, multi million pound projects that have innumerous numbers of people working on any given area of the project package. The strict legal issues and constraints of constructing in London turns the attention even further on ensuring every element of the build is done without error. However as anyone who has worked on a live project will know, almost nothing is ever executed


SITE VISIT
0102 03 Description: fahoifho afo idsahgkshag oifasoif klsioiohf ajsjfsuhsa isiowheb sl oaifhos ahfjksfowhef afk. Description: fahoifho afo idsahgkshag oifasoif klsioiohf ajsjfsuhsa isiowheb sl oaifhos ahfjksfowhef afk. Find and assess a potential site. Gain entrance into site. Bypass the standard views and search out The Formless.
completely without fault, and although some of these can be attributed to human error, I believe the formless nature of the world works against the rigid constraints of our construction codes.

To examine this, I arranged a visit to a live project at one of the largest London sites currently under construction. The mixed used (commercial units, hotel and residential) multi-storeys sit in one of the most rapidly developing and desirable areas of London, and are owned by a large international conglomerate and are funded by foreign investment. Despite the finding and countless man hours that are being poured

04
Document and reflect on findings.
Description: fahoifho afo idsahgkshag oifasoif klsioiohf ajsjfsuhsa isiowheb sl oaifhos ahfjksfowhef afk.
Description: fahoifho afo idsahgkshag oifasoif klsioiohf ajsjfsuhsa isiowheb sl oaifhos ahfjksfowhef afk.
Description: fahoifho afo idsahgkshag oifasoif klsioiohf ajsjfsuhsa isiowheb sl oaifhos ahfjksfowhef afk.

84
70
into the project, elemental forces still have found their way through; currently, some of the luxury penthouses are experiencing problems with mould. In line with my study of the Formless, I hope to document this incursion. The examples I found, although undesirable to the companies working on the project as they represent additional cost to resolve, I found to almost be beautiful. The clinical nature of the site, perched above the London skyline, entombed in steel and concrete, yet nature had found a way to force itself through in an almost whimsical pattern. The dichotomy of the patches scattered haphazardly across the walls sat at odds with the meticulous plans and floor marking I was shown constraining every element of the design.

I also found interesting patterns in the protective silicone spray that protected window fixtures - although not part of my original interest in the site, and perhaps not even formless, the patterns nevertheless drew my eye. Again, finding the most beauty in such a luxurious space in the temporary practical elements, is at odds with the dictated function of the spaces.


Description: fahoifho afo idsahgkshag oifasoif klsioiohf ajsjfsuhsa isiowheb sl oaifhos ahfjksfowhef afk.


My categorisation of the pervasive began with the study of Teresa Stoppani’s work with dust and formlessness. She writes of dust’s pervasive nature, invading every nook and cranny, made of both us, the user, and the architecture itself. In a broader sense, I found that pervasive became a key indicator of what could be identified as ‘Formless’. It is inherently uncontrollable, cannonballing through our best laid plansexemplified by my site visit of one of the new multi-million pound developments


in Vauxhall, that despite being held to gold industry standards, were fighting a losing battle with mould encroachment in their penthouse apartments. Other instances of pervasiveness were found in the sprouting of moss and mushrooms. Merlin Sheldrake describes in his work ‘Entangled Life’ the complex network

 Vauxhall in the clouds
Overgrown door in Greenwich
Grimy concrete in Vauxhall
Vauxhall in the clouds
Overgrown door in Greenwich
Grimy concrete in Vauxhall
SE10
Mould growth in multi-million pound new development, Vauxhall
PERVASIVE // TYPOLOGY SW8 74
of filaments below the Earth’s surface, linking all mushrooms in one subterranean nervous system. These instances are almost spots on the skins of our cities, where Mother Nature breaks our best laid plans; one chink in the armour and it will be monopolised. Many
artists study cracks, and the appearance of weeds is becoming a popular topic amongst architects and designers. These mini ‘urban jungles’ represent a loss of control from the city designers and planners, and indicate L’informe’s reclamation of all.
Once all the images over the year had been categorised, I narrowed down the 50 odd ‘pervasive’ images to a collection of 17 photographs, all selected for their efficacy in showing the pervasive nature of The Formless. These images tended towards

depicting mould encroachment, and relied partially on the photographs taken during my site visit to the new development in Vauxhall.


 Damp encroachment in multi-million pound new development, Vauxhall
Unexpected mushroom amidst concrete & steel in Battersea Arts Centre
Decades of grime in the London Underground
Damp encroachment in multi-million pound new development, Vauxhall
Unexpected mushroom amidst concrete & steel in Battersea Arts Centre
Decades of grime in the London Underground
EC2R
Peeling paint, damp and mould in a disused section of Moorgate station
SW11
75
PRINT TEST
Once chosen, I spent some time testing various papers; the goal was to show the passing of time and in


D EV E LO P M EN T
some ways decay but at a human, filmable timescale. My initial thoughts were paper getting wet, or stone

RIAL
paper decaying in sunlight, however the timescales of these were prohibitively slow - paper is surprisingly sturdy even when exposed to water, and the stone paper decays in sunlight overexposure for months or even years, not days. To resolve this, I conducted a series of tests on a variety of water soluble materials
used for sewing patterns, that are then able to be washed aways once the design is threaded onthese pages work well, rapidly dis-
MATE
PERVASIVE // REPRESENTATION 76

















77

PERVASIVE // REPRESENTATION
solving on exposure to both tap and rainwater. Following a series of test prints, I found a suitable paper that was able to run through a printer without the ink dissolving the paper. I also tested this paper in the rain and it rapidly dissolved in aesthetic dapplings, before melting away into nothing. When printed, these images almost look like they are on tracing paper, with the photograph showing

BIND
through multiple pages as well as on the reverse. I found this translucency added an effect of impermanence, and contribut-



ed to the overall feeling of transience and temporality.
Once the material testing was complete, I needed to find a suitable method of binding. Glue was not viable as it would dissolve the paper, so instead I considered a sewn binding.

MATE RIAL
SEW
79
PREDESTRU CTION // OBJECTHOOD

PERVASIVE // REPRESENTATION
Traditional Japanese stab binding holds all the pages together with the thread passing through all the pages at once; although a nice aesthetic, this would prevent the book from lying completely flat - a characteristic I felt was important when turning the pages and allowing the rain to saturate them. To solve this, I sewed each page individually by hand, starting at the back and working forwards. As I was inventing a suitable stitch to suit the binding and material requirements, at first these stitches were loose and uneven, however as I perfected the technique they became more regular. The result is that the binding of the

book appears to deteriorate as the book progresses, reflecting the intent for the book itself as well as providing a visual record of the development of my own skill set.
Once bound, the text block was sewn onto the front cover - an unusual method as typically this would be glued. The resulting look was far from the neatly glued books of the portfolios 01 & 02, yet provided a more authentic record of the methods used to create it. The criss cross of the stitching also added texture and added sensory tactility, completely the style of this typology. The cover was one of my favourite images from the typology study (an ancient pathway trodden down and overgrown), printed on soft canvas fabric, with the book’s title, ‘Pervasive’, printed in small white lettering on the top left hand corner of the front cover.


To film the embodiment of the book’s subject, pervasiveness, the book needed to undergo rapid deterioration. Waiting for the perfect day with consistent rainfall, I set up outside, with the camera sheltering from the elements beneath my umbrella (leaving myself out in the wet). The scene presented an odd dichotomy; the practical elements safely dry behind the scenes whilst the (in some ways) more valuable piece of work was left out, exposed. Whilst filming, I turned the pages at regular intervals of 1 minute, although also allowed the elements to influence the timings; if a gust of wind turned a page for me, I allowed it to do so, taking this as a sign that I should not try to overtly control too many elements of the outcome.

PERVASIVE // REALISATION
82
Scan for full video
START END












83
The remains of the Pervasive typology after exposure to rain. The paper did not dissolve completely, but rather changed form, tkaing on an almost fabric-like quality, with the ink bleeding from one image to another, creating new relationships between the photographs. The paper used to separate the pages during filming was also embued with some of the imagery, creating a shadowed imprint of L’informe.


PERVASIVE // REALISATION





85
The success or failure of the pervasive typology study lies in the level of control I believed to exert over the final outcome. Although the final book did not disintegrate completely, there were practical limitations (being able to physically turn the page) that prevented this outcome. Rather the remaining book shows signs of wear and disintegration in places, but is almost pristine in others. The inconsistency of the rainfall had a large impact on this; by relying on the elements to undergo this transformation, I was unable to control the change of the book. This became a more inherently formless practice therefore, as even elements such as the timings for turning the pages were not always static - the wind also played a part as much as the rain. Overall the film became at once aesthetic and anti-aesthetic; some elements becoming more beautiful, others deteriorating. I felt that this was successful as an embodiment of the pervasive; although beauty lies in the eye of the beholder, the encroachment of dust and damp is, through the paradigm of formlessness, equally valid as a flower sprouting through cracks in the pavement. I believe this piece could be improved with the addition of a perfomative aspect; with an audience, I could continue the practice until the book disintegrates completely, without the consideration for needing to present a tangible object as in this case.
PERVASIVE // REFLECTION
86

EMERGENT




1
I began by mixing Agar powder, a natural substance found in seaweed, with distilled water. This mix was then boiled, and poured into a selection or petri dishes.


GROWING PHYSARUM POLYCEPHALUM
2The agar-filled petri dishes were then left to cool with the lids on to maximise moisture content. This process was then repeated with various concentrations of agar to find the optimal growing environment for the mould.
3I placed oat flakes (the optimal food source) following the key points identified from the weave of the basket. I tried a variety of layouts (intending to layer them) and on different size plates and agar solutions.
4A small piece of dried Physarum Polycephalum was then placed at the centre of either dish and activated with a drop of distilled water. The plates were then placed in a cool, dry place (my kitchen cupboard) in a enclosed container and left to grow for a few days before examining the results.

Unfortunately due to my kitchen not being a sterile lab environment, (de spite my best clean ing efforts!) contamination from other sources occured forcing the slime mould to compete with other organisms. Al though unanticipated, this reflect the nature of working with a formless biological entity, and did not impact my ability to create a pattern from these experiments. This was also the benefit of using multiple test plates, so that the option with the clearest growth pattern could be selected as the via ble option and used as a base to trace from. This selection is shown to the right, including the contamination from other or ganisms causing discolouration.

6I continued growing the slime mould for future experimentation, and was intruiged to observe it explore out of the petri dishes and into the containers in further search of food.



5
REPETITION
Repeating the ‘Bio-abstraction’ experiment under lab conditions.
Although I was satisfied with the outcome made from my kitchen in time for the patterns of power deadline, I wanted to repeat the experiment in lab conditions to prevent contamination where possible. As I had the Making Waves residen-
cy coming up, I got in touch with the Grow Lab over at CSM to see whether I would be able to use their timelapse booth to repeat my experiments, and fortunately they allowed me. To repeat the experiment, I used the same strain of Physarum Polycepha-
lum, and a larger agar plate supplied by the grow lab, again with the oat flakes placed on the same grid with the slime mould at the centre. This was then placed in the timelapse machine and allowed to grow - you can see the outcome of this by scanning the QR code.

SCAN FOR TIMELAPSE
Stills from timelapse shown to the right.
26
92
shown








Once this growth had completed to a suitable level, I took the plate home with me, hoping to preserve the growth pattern produced by the slime. The mould leaves ghostly tracks when moving through the agar, when it no longer deems that arterial route as useful to keep as part of its resource network. I found these tracks to be of interest, particularly how the light passes through the plate. To highlight this ghostly network of the inactive mould, I

suspended the plate, photographed the shadows cast when light is through them. In this I froze the timeline documented the lifespan, an unusual nomenon when observing Physarum Polycephalum as this is typically ganism in constant flux. doing so, I tread a bound ary between formless form - at the end, the man need for control desired form outweighing the transient nature L’informe.

LAB SET UP
93
The Grow Lab at Central Saint Martins
When considering how to capture the traces of the slime mould I found a challenge; whilst the shadowy traces left behind cast dramatic shadows, it is difficult to photograph them in a way that highlights the intricate nature of the filamental networks. The best solution I have found is the use of cyanotype papers, which reacts with sunlight and creates a print of whatev-
ow across the surface at the time of the film development. When trying this with my own physarum polycephalum samples, the results were varied: some came out too murky, a result of the agar being too thick, in others the detail that was initially shown on the print became less visible once the paper was washed and allowed to develop. Here I have shown examples of papers both pre and post development, so that the


30
CYANOTYPE
94
The best part of this method of capturing the mould is that it does not kill it; resents a brief moment in time (2 minutes of development), a part of the mould grows and changes rapidly, these patterns were never seen in the same


95
FORCES
RHYTHMS,
MAKING WAVES
At the end of Unit 1 a UAL wide email was sent out advertising ‘Making Waves - Scientist in Residence - Rhythms, Patterns, Forces’, a collaborative exploration in partnership with the Tokyo Institute, who were seeking 20 artist “test subjects” to open new avenues of research, and potential generate paradigm shifts within the bounds of their scientific exploration. The programme was open to all post graduate and doctorate students across UAL, and applicants were required to complete a series of assessments and pen various expressions of interests. At the start of 2022 I was delighted to find out
that I had been accepted onto the residency.

“OPEN CALL: We invite postgraduate students from across UAL to join an exciting experimental project designed to interrogate and reimagine contemporary scientific research centred on the dynamics of living systems across scales.” To see a snippet of the taster session which provided an overview of the aims of the week, please scan here.

34
PATTERNS,
SCIENTIST IN RESIDENCE 2021/22
UAL IN PARTNERSHIP WITH THE TOKYO INSTITUTE
BRIEFING 96
The week aimed to answer “How can art and design practices and transform scientific research?” le this, the residency into two parts; tion and demonstration a variety of professional searchers in the sign, science, philosophy social science. The experimentation by the students verse disciplines




To begin with, we were to Professor Masahiko Hara, partment of Chemical Science neering at the Tokyo Institute ogy. Professor Hara’s work areas of Nanotechnology and Bio-Interfaces, Emergent Functions, Natural Intelligence to name sented his research in the emergent that spanned from electrical cells, through to starling murmurations firefly lights. His research mould Physarum Polycephalum ly interested me due to its intersection

my own work. The other leading scientist who worked with us was Dr Thomas Iskratsch from the Division of Bioengineering and Biomaterials, who’s research into cellular behaviour aims to tackle heart disease via the biochemical behaviours at a chemical level. To answer this question, he developed technology that allows us to place heart cells on engineered surfaces which have stiffnesses emulating embryonic,

healthy or diseased adult hearts, as well as specific shapes that the cells adhere to and take up these patterns and shapes. By manipulating these cellular components we can learn the parameters that determine how a cell behaves in its environment, and thus identify drugs that will enable cells to function healthily combating heart stiffness (the cause/ symptom of heart diseases).

36
98
RESPONSE
In addition to Professor Hara and Dr Iskratsch, we were introduced to the works of UAL’s Heather Barnett and Dr Betti Marenko. Heather Barnett’s research focuses heavily on exploration of the design potential of slime moulds, and who I have referenced heavily within my own research during Unit 1. Dr Betti Marenko is a reader in Design and Techno-Digital Futures, and consultant philosopher, who introduced a variety of philosophical principles that related to the scientific research we were interrogating, offering dynamic new paradigms through which to approach and direct our questioning. The first few days followed the format of a digital presentation online, in a working from home setting, where we were introduced to the concept set out above by the key researchers working in the residency. In the afternoons, we went into Central Saint Martens campus to work on physical exploration and experimentation in relation to the


principles introduced to the morning sessions. Some sessions included working slime mould Physarum lum, as well as with advanced oratory equipment which given training session on The first experiment we was working with the slime and altering their environments see how they would respond change in stimuli. In groups, ated various topographical for within Petri dishes for to traverse, along with a We then introduced four strains of slime mould (two an, a Japanese and North varieties), the studied and their responses with time eras.
In the second we worked with Dr design our own nano see how the muscle cells these environments. An the nano etchings is that furniture or ‘chairs’ for










99
cells have different preferences when it comes to certain shapes; they like curves in particular. With this in mind, we were all tasked with creating an etching pattern that would be engraved onto electron microscope slides, covered with a dyed wash containing the cells, and examined to see how the cells were reacting to each of the designs. I chose to create a simple design (as I felt overcomplicating the design wouldn’t give enough differentiation in the surface for the cell to react to) adapting the Yin Yang symbol to add connected curved surfaces. I hoped the cell would take on the form of the smooth curve, and the dot, avoiding the rough etched surface leaving this as negative space. The experiment was very successful, with the cells reacting to our designs to varying degrees. I was delighted to find many cells had interacted with my design, and were behaving as I had anticipated.
The final session we had with the experts was with Dr Betti Marenko, where we examined a selection of philosophical principles through which we can alter the paradigm that we approach both art and science. Two of the principles that interested
me the most were Uncertainty and Perspectivism. We were then divided into groups based on our common philosophical interests, so I worked with the group who were also interested in Perspectivism. We were tasked to create and agree on a question that linked our common interests, that we could explore and interrogate for the rest of the residency. We began by considering questions along the following lines of thought:
- To be human is to have Ego.
> Ego = Soul?
> Ego = Top-down design
>The opposite is a bottom-up approach.
- Could emergent bottom-up behaviours equate to ‘without soul’?
- Does anything ‘other’ than human find value (comfort) from scientific (religious) explorations?
- Does selfless scientific research exist?
> Ego, the soul
> Human-centric histories
> Assign narratives to the non-human
> Religion/Science
By narrowing down these questions, we settled on
FUTURE PHILISOPHICAL PILLS
DIAGRAMMING/
METAMODELLING FICTION
MYTHOPOESIS UNCERTAINTY ACTIVISM
ANTICIPATION
ABDUCTION/INDUCTION/DEDUCTION
PERSPECTIVISM
TRANS-EVERYTHING
our group exploration to be “Does Selfless Scientific Research Exist?” We found this an interesting line of investigation as when considering scientific research through the lens of Perspectivism, any human intervention could be seen as selfish, even if it
appears to be for the benefit of the non-human. I personally found this line of questioning interesting, as I found it intersected in a very tangible way to my own discoveries and explorations of the Formless. As a group, we decided to begin investigating this question with a site visit, to collect samples and document non-human habitats from the local and surrounding areas. We set out to not disturb any eco-systems, nor harm any living creatures in this task, however when we returned to the laboratory we discovered that we had kidnapped a variety of small life forms within our samples (name-
40
100
bugs and discovery uncovered further at the sammicroscope, discovered vast communiecosystems living samples. We wracked our quest selfless sciexist, we had acted selfrepresent these set up an crime scene, suspects (ourprofessors, peers), ‘victhe crimes miscellany the ‘kidnappings/murders’. We



provided red string, and encouraged spectators to make links between the presentation and our actions, gradually resolving the initial question. Each groups responses were documented and continued after the end on the residency. My group felt that a zine would be the best record of our explorations, whilst other produced short films or soundtracks. These will all be available to view online soon. Further to this, I felt inspired to create a few pieces in response to the sessions hosted in the residency, which I detail over the following pages.

101
Cell etching process, top slide shows etched patterns, then ‘Volume ing cell adhesion.





to our site
and the Perspectivist
and
103
Group work response
visit
views. Making connections
solving
Ifound the Making Waves residency to have a lasting impact on my work. It was incredibly influential to experience first-hand the blending of science, political and societal theory, and art under one practice. I feel in many ways, my own research of the formless straddles these topics also, and what I learnt during the residency was taken on into my own work. The hijacking of Physarum Polycephalum for example, was a key takeaway that I have continued to use in my own work, as an organic, intelligent, formless enactor that acts as a representative of what the future of formless could look like. In addition to taking my own learning outcomes forward, following the conclusion of the residency, a film was also put together by the videography team who documented the event. To view this summation of the residency, please scan the QR code in the bottom right hand corner of the page.



104
Scan to read online summary of the residency.




RESIDENCE: CONCLUSION Scan to view entire film.
SCIENTIST IN
Betori Diehl’s THE HEAT -
Niels
2
“illustrates just how fluid the OOO conception of an object can be: Betori Diehl filmed shirtless men on a hot day from his window in Prenzlauer Berg, Berlin, taking the phrase “object of desire” quite literally.”
Application of valuing non-real objects within a real world example of a supermarket chain.

Rejection of Anthropocentrism.

Critique of Correlationism.
Rejection of undermining and over mining
Preservation of finitude. 1
Navarro performing Timeless Alex at the New Museum Triennial (2015)

The artist performs autohypnosis in an attempt to ‘become’ the animal he portrays (turtle). 2

GOLOTNODETNEIRO-TC Y
Eduardo
In Entangled Life, Sheldrake touches on his own version of OOO - a reversal of anthropocentrism instead towards plant-centrism, myco-centrism, and by extension, ecocentrism. He finds that when writing about the entangled network of mycorrhizal fungi ‘roots’ acting as ‘plumbing’ for the plants above-ground, we unconsciously become plant-centric in our worldview, as in typical hierarchy we place plants above fungi, animals above plants, and humans above all else. In his writing he challenges these views by writing from the perspective of fungi and emphasising their role within our environment and ecosystems.
1 IAAC Blog. 2020. Discussion On Object Oriented Ontology – IAAC Blog. [online] Available at: <https://www.iaacblog.com/programs/discussion-object-oriented-ontology/> [Accessed 20 May 2022].

2 Kerr, D., 2016. What Is Object-Oriented Ontology? A Quick-and-Dirty Guide to the Philosophical Movement Sweeping the Art World. [online] Artspace. Available at: <https://www.artspace.com/magazine/interviews_features/the_big_ idea/a-guide-to-object-oriented-ontology-art-53690>.
3 Steve Santer - Exploring the practice of design. 2020. Object-Oriented Ontology and Philosophic Concepts for Design Research. [online] Available at: <http://santer.com.au/portfolio/object-oriented-ontology-and-philosophic-concepts-for-design-research/>.
(image) Bioneers. 2020. Entangled Life: Fungi, the Great Biosphere Builders - Bioneers. [online] Available at: <https://bioneers.org/entangled-life-ze0z2007/>.

3
CEJBO&MSIVITCEPS
FUNCTIONALISM, P E R
(Background: Pamela Rosenkranz’s Our Product (2015)) ForegroundInterpretation and application of OOO in relation to design theory.




From the exploration with Thomas Iskratch’s work on engineering surfaces to manipulate cellular behaviour, and my groups work on deprioritising anthropocentrism and identifying alternate architectures, I planned to further explore this theme in conjunction with the earlier project ‘Bio-abstraction’. For Form//Formless, I planned to reference Rachel Whitehead’s work by casting a floorplan of a typical UK ‘two up, two down’ home, creating an inverse cast. This reversed form, although useless for human inhabitation, offers a more ideal growing or ‘habitation’ surface for non-human life forms - specifically Physarum Polycephalum. The piece, cast in plaster and/or agar, shall take a ‘formal form’, a typical architectural structure (which I have critiqued in earlier discussions of enclosure/disclosure) which is then subverted my removing its functional nature, and finally populated by a formless life form, whose traces will leave a formless alternate of the original form.
FORM // FORMLESS



Rachel Whitehead’s house is both famous and infamous within the artworld. An inverse cast of a London home, the speculative piece reflects on the typically unseen, intimate details of the interior, broadcasting them in a juxtaposition of public display from a monolithic brutalist structure. The controversial work, a home slated for demolition, comments on the housing shortage; coming under fire for the funds
put towards a non-functional home whilst homeowners were evicted from the site.2 This reflection is evocative of the non-functional direction of architecture that I have explored within my earlier enclosure// disclosure explorations, and when exploring housing for the non-human, this felt like an appropriate reference point from which to start.
[Accessed 2 June 2022].
3 Steve Santer - Exploring the practice of design. 2020. Object-Oriented Ontology and Philosophic Concepts for Design Research. [online] Available at: <http://santer.com.au/portfolio/object-oriented-ontology-and-philosophic-concepts-for-design-research/>.
(image) Bioneers. 2020. Entangled Life: Fungi, the Great Biosphere Builders - Bioneers. [online] Available at: <https://bioneers.org/entangled-life-ze0z2007/>.
PRECEDENT
Fig 1 Hoffman, D., 1997. Wot For? Why Not?. [image] Available at: <https://romanroadlondon.com/rachel-whitereads-house-bows-legacy/>.
2 Cohen, A., 2022. When Rachel Whiteread Turned an Entire House into a Concrete Sculpture. [online] Artsy. Available at: <https://www.artsy.net/article/artsy-editorial-rachel-whitereads-house-unlivable-controversial-unforgettable>
Sketchup massing studies for scaling floorplan and envisioning cast outcome
Initial mould from


//
at The Foundry, Camberwell // Poured mould using Herculite strongextra plaster // De-moulding in process, pin and plasticine removed // Unmoulded sterpla cast, ready for moulding reusable mould //



 foam board, pinned together, with plasticine detailing
Plaster casting section
foam board, pinned together, with plasticine detailing
Plaster casting section
To explore this subversion of typical form with the formless, I began by creating scale casts of the ‘standard’ London home that I had mapped. I poured these with an extra strong Herculite plaster, for which I then made clay surrounds. These surrounds formed a clay wall so that I was able to melt and pour in a rubber mix, to make a reusable flexible mould. I found that these mould were reminiscent of the furniture I saw in Formlose Mobel, a collection of formless furniture I examined last term. The fluidity of the rubber abstracted the rigid form of the plaster, creating an interesting juxtaposition of shapes and textures. With the rubber moulds, I then mixed a thick batch of agar solution (comparable to what is used as a growing medium in petri dishes for slime mould habitats) and poured this into the moulds. Once set, I removed the agar, and introduced Physarum Polycephalum to its new home, so that I would be able to study its growth in an inverted human habitat.


I have been unable to fully assess the success of this experiment as at the time of writing, the slime mould has yet to fully populate the growing medium. Nevertheless I feel that I gained

many useful skills in learning about model, and the resultant outcome ment; unable to anticipate the final both existing yet unfinished in a

ADD CLAY SURROUNDS // KEEP IN A HUMID ENVIRONMENT // MELT AND POUR RUBBER //
Fig 1
Noever, P., Hackenschmidt, S. and Rübel, D., 2008. Formlose Möbel. Ostfildern: Hatje Cantz.
UNMOULD // ADD AGAR SOLUTION // UNMOULD // INTRODUCE PHYSUM POLYCEPHALUM ADD AGAR SOLUTION // UNMOULD // INTRODUCE PHYSUM POLYCEPHALUM





required to create such a reflection of the experiproject is still in flux,


 Fig 1. The rubber mould, unrefined the final model, is reminiscent ‘Armchair’ 1964, which I came book Formlose Mobel [Formless
Fig 1. The rubber mould, unrefined the final model, is reminiscent ‘Armchair’ 1964, which I came book Formlose Mobel [Formless
111

Throughout the process of collecting photographs of The Formless, one category that I had identified continued to elude me. From my research and reading, I had discovered the the emergent nature of The Formless could hold the key to its efficacy in practical use in the future, yet finding images of this occurring in the architectural landscapes around me proved futile. Inside it is visible in the murmurations of starlings, the communication between cells of the human body, in the interaction of atoms and magnetic fields. Increasingly humans are harnessing this systems theory and implementing it within the fields of artificial intelligence and AI. Merlin Sheldrake posits a future of organic computation by harnessing the network of mycelium created by mushrooms all over the world, creating a vast architectural supercomputer capable of growing habitats that respond to their environmental conditions. The technologies available to envisage this future are still in their infancy, however formless users such as Rose and Ricciardi in their Formless 01 Manifesto identify pioneering architectural and design project that use cutting edge technology to create emergent robotic forms that carry on to inadvertently exhibit formless properties. I believe it is the blending of these two fields that offers the potential for true formless utopia.

To represent this dichotomy of the formal architecture of our cities and the emergent formlessness found within, throughout the year I have been undertaking a series of experiments named form // formless. The culmination of these works is the final book in my typology series. Instead of housing photographs of The Formless like its counterparts, this final typology instead houses a colony of Physarum Polycephalum, the formless enactor that I have worked extensively with over the duration of the course. Its colonisation of the formal structure of the book represents the final mode of embodiment of The Formless over this book-object series.
To construct the book, I started by making the cover in the same style as the other typologies; an approximate A5 hard cover book, covered with soft canvas fabric that has been printed with an image of a group of insects shimmering in the light that dapples across a country path. Their patterns of movement were confined to an ever-changing orb, at once always moving individually, yet remaining a static presence as a whole. This cover encloses a series of pages, constructed from various mesh types, which I test-

ed with the Physarum Polycephalum to evaluate which fabrics would provide a suitable growth environment. Once confirmed, I cut these meshes into an A5 page size, and formed supports for the edges out of balsa wood. I then punctured these strips with a series of regular holes, and sewed them on either side of the mesh to create a sturdy structure that would give each page rigidity.



EMERGENT // REPRESENTATION
114
Process
I then dipped these pages into a specially tailored mix of Agar, which I had experimented with the proportions to get the right level of consistency that would percolate the mesh, yet not run off before setting. I then allowed these to dry (creating a bizarre-looking, laundry-day effect in my kitchen!) until the agar medium was set. To ensure a formless habitat and growth pattern as possible, I introduced the Physarum’s food source, oat flakes, in a random fashion, pressing the flakes into sections of the agar where it had settled in thicker drips. I then slotted these pages into a box fitted with thread inspired by the housing for honeycomb in bee’s nest relocation, with each page supported near, but not touching the next. Following this, I introduced the slime mould colony that I had been cultivating, dropping it onto the pages in a random arrangement. Over the next few days I allowed this colony to spread over the pages, creating a new habitat for itself.
The Physarum Polycephalum adapted to this new environment remarkably quickly. Having only been grown in horizontal petri-dishes prior


Continued overleaf...

The Book-Object




EMERGENT // REPRESENTATION 116
to this experiment, I had no trouble navigating any of the orientations of agar presented to it, quickly spreading out and dominating all the pages. To house these new habitats, I crafted simple page supports out of balsa wood, and cut grooves into the cover to support the pieces, then fixed them in place by sewing these onto the outside cover. These pieces simultaneously allow the book to close and the page slot horizontally in a stack, but also fit into the holder when the book is open to allow the audience to see the slime mould growth in three dimensions. Once added, the habitat pages slot into the cover to form one complete piece. This book forms the final typological book-object that I will display at the exhibition - an opportunity to introduce these performative ‘live’ works to a wider audience.

The Physarum Polycephalum adapted to this new environment remarkably quickly. Having only been grown in horizontal petri-dishes prior Continued overleaf...




EMERGENT // REFLECTION 118
to this experiment, it had no trouble navigating any of the orientations of agar presented to it, quickly spreading out and dominating all the pages. To house these new habitats, I crafted simple page supports out of balsa wood, and cut grooves into the cover to support the pieces, then fixed them in place by sewing these onto the outside cover. These pieces simultaneously allow the book to close and the page slot horizontally in a stack, but also fit into the holder when the book is open to allow the audience to see the slime mould growth in three dimensions. Once added, the habitat pages slot into the cover to form one complete piece. This book forms the final typological book-object that I will display at the exhibition - an opportunity to introduce these performative ‘live’ works to a wider audience.
Once the slime mould had grown over a period of 4 days, I decided to reintroduce it to its book form. Although having tested the construction of the book prior to adding the agar, and found the wood supports along the spine to provide sufficient support, I had not tested them with the agar added to avoid contamination and to keep them sterile before adding the Physarum Polycephalum. When fitting the pages into the book, I found that the balsa wood had become saturated with the moisture required to keep the slime mould alive. As a result, the thread holding the pieces of edge support together no longer provided enough support to prevent the water-laden, and now flexible, balsa wood and the additional weight of the agar in the intended positions. Despite this, I was still overall satisfied with the effect, and feel that the object still carries its intended embodiment of its formless characteristic.

119

EMERGENT // REFLECTION
Some of the finished pieces of the Emergent typology developed interesting and unpredictable patterns from the slime mould’s growth. I particularly liked the effect of the unpredictable networking of filaments overlaid onto the regular grid of the mesh. It made me think about the formed boundaries we enforce in many of our cities, by way of urban planning, particularly in the New York grid system, with a representative of the formless chaos finding a way to undo the regular predictability. Going forward, I plan to repeat the experiment, creating pages with a sturdier support and a thinner layer of agar, for presentation at the exhibition at the culmination of the course. In some ways though, I feel that this reflection of imperfection is part of the way of working with The Formless should be. Despite the best laid plans, certain elements will always go wrong, and it is beneficial to look for the beauty and benefit in failure, as well as assessing whether resolution is indeed necessary. I also feel that a development of this experiment would benefit from a live installation, with the piece changing each day that visitors see it. When performing this experiment, I also had hoped to record it to produce a timelapse shot of the growth, however I lacked the equipment necessary to achieve this, a goal that I would hope to reconcile in the future.

When making my Unit 1 portfolio in InDesign, I had always envisioned it to be a physical object. With this in mind, and my newfound skills from the bookmaking workshop, I decided to put these to the test by printing and assembling the portfolio myself. Due to the formatting of the in design file, I chose a perfect bound format (glued) along with a cover I made myself. I tested using the muslin I experimented with in some of the sequences, however I felt that it was too translucent so went with a printed matte paper.
04
The covered boards are then aligned with the book block, and the end pages glued to the cover. The book is then allowed to dry under some weights to prevent from warping.



03
The boards are then positioned and glued onto the cover, with the end flaps then being folded over and also glued down.
Next, the boards are cut to size, with a small amount of overlap to the size of the book block.

First, the book block is stacked with end papers and glued, then left to dry.

74 ADD END PAGES // TAMP THE BOOK BLOCK // GLUE // LET DRY // MAKE COVER // CREATE CASING // GLUE // ASSEMBLE PARTS
PORTFOLIO // UNIT 1
0102
lthough this was successful as the assembly of a book, and I am pleased with the final outcome, that it did not reflect the excitement for the portfolio’s contents. When considering Marshall McLuhan’s famous





phraseology “The medium is the message”, I felt that this medium did not reflect the message. Although it was good practice and an achievable place to start, going forward I plan to aim to create any physical versions of my work in a more formless format.

A
When making my Unit 2 portfolio, although I had planned to make it more reflective of its subject, embodying some formless characteristics, I found instead I was more useful at the time to hone my bookmaking skills. Using similar methodology to the Unit 1 portfolio, a bound the second portfolio also by hand, with the outcome being a marked improvement on its predecessor. My skills and knowledge in paper types and binding methods had improved vastly, and this offered the perfect staging exercise prior to making the typology books and manifesto. I also felt that the execution and craft of these other works were more important in reflecting the embodiment of L’informe, and that the portfolio reflected more of the research and methodology behind the pieces. I plan to similarly bind this Unit 3 portfolio, to create a set of work that functions as a uniform set.


PORTFOLIO // UNIT 2

Critical Research Paper












For my final CRP, I built on what I had presented for past submission; a duality in form between the formless and the formed. I pushed it even further for the design of this submission, with the formal essay mimicking the construction of the formless, whilst adhering to the submission requirements of the online portal. When writing the essay, I struggled with the order of the sections; they seemed to fit well in many different configurations. I realised that with a formless structuring I could leave it up to the reader to choose the sequence in which the essay is read. By adding this element of chance to the sequence, the connotations of the essay shift slightly with each reordering. To create the physical work, I sewed the four key pieces of the essay together, in a way that each is able to be unfurled to completely cover the other sections. A single visual appendix was then annotated by hand that sits over the top of any of the four sections, allowing the reader to draw different connections from each part from the same appendix. These were all bound into a hardcover, with the introduction, coda, and bibliography hand bound with thread into the front and back on single slides of trace. The inside of the hard cover then houses all of the illustrations. The formatting of the formal essay mimicked this arrangement, with the text blocks split into four, with snippets of the appendices encircling the main contents.


127



129


130


131


132



EXHIBITION
WARM UP
For the trial exhibition back at the start of summer, I chose to present my film as a simplistic piece of videography starting with myself pulling a book from a shelf and slowly leafing through it. Inspired by Dan Walsh’s 2008 art piece ‘Textilene’, I was interested in the objecthood, form and materiality of a book holding equal importance to its contents. To test my idea, I chose to use my Unit 2 CRP as the book to film, slowly working through each page. Over the top, I recorded audio of myself narrating the work, combining the visual and auditory experience as one. As I had attempted to present the writing with a formless methodology, the visualisation of the essay contributed to the overall experience, with neither the writing, nor the visual functioning as well without the other. On the previous page, you are able to see the film poster myself and a couple of my peers put together for the show, naming it 420 seconds, a nod to the 7 minute time limit that was placed on our films.





























138









139



EXHIBITION // TYPOLOGY
140
The final collection of typology books, pre-formless transformation.
For the final exhibition, I plan to follow a similar format to the previous film submission. My final output from the course centres around the typology books, whose filming of their destruction will form the basis for the visual presentation at the conference. I feel that this is the final level of completion for their journey, as I would have preferred to make them a piece of live performance art. I hope however, that the filmography of their journey can take the place of this live version. For the audio, I plan to record myself narrating the words from the manifesto, thereby creating connection between the two pieces, and hopefully tying up the project into one cohesive work. For the physical element of the exhibition, I will display the remnants of the typology series, placed as a set of four on book rests, encouraging interaction from visitors. The only exception to this will be the Emergent, which will be placed in a sealed clear perspex box for hygiene and safety. Alongside these, will be printed copies of the manifesto, for those who are interested to take away with them. Lastly, a scannable QR code will take visitors to this portfolio, and also the final critical research paper, for a comprehensive explanation of the entire project.


141
Form and architecture are two words that are often synonymous with each other; one cannot be without the other. tunity to exert the maximum control over every element of a design. This embodies the typical approach to design down. Architecture is lacking fulfilment in its duty of enclosure and disclosure. The decline in significant meaning that permeates every aspect of modern life, so can the effect of climate change be accredited to this same period. security, lacking the art and beauty that conveys truly meaningful form. Disclosure, where architecture denotes Historically, religion has dominated everyone’s daily lives, across cultures and countries, yet today, in the face of er fields. One of the greatest challenges facing almost all industries is that of climate change, and any architecture new building must adhere to multiple restrictions and guidelines for sustainable construction, these standards architects to pointlessly play with forms. Current design falls short of achieving meaningful form, whilst simultaneously with creating form sits directly at odds with the natural environment. The buildings we construct are a far cry shapes and structures that they would never naturally create. The dichotomy set up between architecture and forms that only appear to be in beautifully harmony with their surroundings. The reality is a brutal holocaust that serves its purpose, then we should liberate the obsession with form altogether, and reap the benefits that could ymous with control over form, so to radicalise this practice we must consider the antithesis of form; the form-less. a term introduced to the world by controversial philosophical intellectual George Bataille in 1929, who first wrote ty in all of us. He hoped to use The Formless “to bring things down in the world”. Bataille countered his peers' obsession FORMLESS IS AN OPERATION, yet this operation has yet to be harnessed in a functional way. When considering its disregard for aestheticism (although not without beauty), a disruptor - these are also reflected in some of the form”. Both functionalism and formlessness have strongly aligned principles, yet the latter has rarely been explored quish previous expectations, allowing us to tackle projects anew. Formlessness offers the opportunity to break process. When discussing The Formless, the predetermined framework of what is accepted and expected must is disruptive, egalitarian, and seeks to bring all that is formal and high in the world down to an equal level of change, in a loose sense, behaving as though ‘alive’. This leaves room for each user of informe to take it up for chy, the reordering to prioritise other functions over form and allow for a bottom-up approach. The Formless within form // to construct // to designate, find benefit in the antithesis of this, deconstructing form, disrupting order? tecture, Bataille would wish for formlessness to take it. A revival of functionalism is due, through the lens of the and living architectures, sitting in the intersection between computational and biological sciences, art, architecture architecture and the built environment, the question of its application becomes philosophical. The Formless disrupts use. Fungi, or indeed any decomposer, can be assessed as an enacter of the Formless; by taking form and breaking form. The process of formlessness to form and its return to formlessness is present in all life cycles, yet our human systems, but we are not acting fast nor dramatically enough. It is time for more radical action to be taken. We must approach to design, we must destroy the top-down approach to creation, where the architect or designer relies and in extension, all that is human-centric, we create an alternative radical worldview which views all, both human ruption, our humanistic egos blinding us to the damage our technological advancements can cause. Increasing ical designs with organic forms that respond to their environment and thereby are allowed to shape themselves. constantly transmitting data through its entangled roots. Fungi does not act altruistically, rather playing God, deciding bio-mimicry and bio-integration, and the comparatively recent discovery of this global mycelial network, imagine vironment via an entangled web of subsurface network sensors; a human ecosystem in harmony with the organic. creating new modes of design; biomimicry, emergent and living architectures. Some fields of design are heading design are being made, whilst the approach towards living architectures and bottom-up design also is being explored. widely available and does not extend to the free growth of dwellings as conceptualised in fiction. These are the ality of a city over the form that it takes, whilst uplifting environmental concerns to the same level as societal equity success, and Environmental consideration. THE FORMLESS CITY: exists within our existing cities. is unplanned, celebration of chaos. When L’informe is used as a paradigm through which to explore all these structures, one need. The Formless already exists within our urban fabric; why not embrace it from the inception of our designs? is emergent; when straying too close to fields such as biomimetic actuators they become too limited in their function, symbiotic habitats that function equally with or without us, could be key to developing a sustainable formless way whether for our benefit or not loses its true formless characterisation. The Formless can really only be found. becomes formless or not is of no matter; Perverse the definition of L’informe - redefine its operation to that of outputs as opposed to the final form, create meaningful architecture that sustains and enriches life, resolving suggest an alteration to the role, to become the enabler and protector of the process of successful economy, equity and active participation in the biosphere and habitat. It is human nature to experience the increasing need to same effect; the greater the control we are trying to exert on our surroundings, the greater the spiral of destruction and instead focusing on the processes and needs of the occupants and our surroundings. Achieve peace by at once methodology that paradoxically, via anarchy and destruction, combats a world that is intent









other. Architects are obsessed with the manipulation, creation and manifestation of form, grasping at any oppordesign where the form is created as a whole and then filtered down through every element of the building, i.e. top meaning of form in architecture can be traced to the industrial revolution and the rise of the influence of technology period. On an intimate scale, the architecture that houses our daily lives has been reduced to a box of moderate denotes a higher power, which makes our lives visible and meaningful, helped us make sense of the world around us. of scientific and technological progress atheism is on the rise. This should leave room for achievements in otharchitecture that is created today must be created with suitable environmental considerations. Although almost every standards attempt to minimise the damage done, rarely eliminating it and not contributing to the solution. This leaves simultaneously proving to fail to prevent the increasingly apparent destruction of our world. Architects’ obsession from organic structures that naturally form, and the building materials that we construct with are forced into the environment is this; Architects are wrestling the elements from our environment into precisely considered that has pushed us to the edge of total world collapse. If architecture as creation of meaningful form no longer could be achieved through this approach. To achieve such a goal requires radical action. Architecture itself is synonform-less. L’informe / The Formless/ formlessness / formless / anti-form / informal / de-form / informe. ‘L’informe’, wrote of l’informe with intention for its introduction to become a methodology to celebrate the debased humaniobsession with sublimity and aestheticism with L’informe, a key factor in understanding L’informe is that THE considering some of the key properties of formlessness; the prioritisation of function over form, its nature as a process, the values of Functionalism. Le Corbusier “denigrated the use of ornament” preferring instead the use of “pureexplored in architecture. By changing the paradigm through which we approach architecture, we are able to relindown the obsession with form, instead focussing on the process of making and the offshoots created from that must first be removed. L’informe, allows each user to interpret or implement it in the way they see fit, as long as it chaos and disorder. The Formless is at once noun // adjective // verb. L’informe are always in a state of flux or use in their own way. The Formless has shifted its meaning, away from being anti-form, but rather anti-hierarwithin the confines of architectural practices is radical; why would a designer, whose modus operandi is to give order? Architecture was the closest to sublimity that humankind could reach. When viewing today’s world of archithe formless, implementing technologies currently being discovered in computational design, deep AI, emerging architecture and design, societal and political studies. The Formless can be found everywhere. When applying it to disrupts anthropocentric priorities, disregarding what we esteem, existing both in and out of the realms of human breaking this down via a variety of processes, they are using The Formless operation, creating formlessness from human interventions break this loop. We attempt to soften our interventions and mimic naturally occurring ecomust turn away from our human-centric perspective to accommodate the non-human. To radically change our relies on ego and presumption of knowledge of others to form a suitable habitat. Instead, by decentralising the self, human and non-human, living or object, as equal. Our anthropocentric viewpoint is the cause of the climate disIncreasing numbers of creators have begun to explore a new approach of working from the bottom up, by way of biologthemselves. The Wood Wide Web, is a mycelial network that spans the entire globe, linking all plants and ecosystems and deciding which plant life to support in a ‘take now’ - provided it will ‘pay later’ trade off. With advancements in imagine the human harnessing of this network, creating growing cities that respond to future changes in their enorganic. Computational design and nanotechnologies combined with formulae time-tested by Mother Nature are heading in a way that hybridises these approaches; as technology develops, strides in computational and adaptive explored. The concept of self-healing buildings feels more within reach than ever before, yet this technology is not fields that could radicalise our architectures into free-forming living cities. This would prioritise the functionequity and the economy. Actively participating in the biosphere. THE PERFECT CITY: Social Equity, Economic unplanned, sprawling, growing unchecked, tumultuously unbound. A living urban sprawl. Unintentional wastelands. A one is no more architecturally significant than the other. Favelas and slums exemplify creation stemming from a designs? Biomimicry offers opportunity for design approach to L’informe, however this must be limited to that which function, their form too highly designed to be considered formless. The de-prioritisation of human use to create city. Utilise ecocentrism and philosophical theory. True L’informe, once represented, applied, or altered in any found. But use it as a lens, an aide, to alter your paradigm or approach to a task or design, whether the output of form produced as an output of function, rather than an end goal in and of itself. Embrace the process and its resolving the many challenges that we face. I am not attempting to nullify the role of the architect completely. Rather, equity and environment; thus achieving a formless celebration of process and exhibition of the human experience rebel in the face of tightening constraints and rules. It seems then that our surroundings are experiencing the destruction that seems to occur. Would should be loosening that grip, relinquishing control over the aesthetics of form, once progressing scientific innovation and combining it with base humanistic living, relinquishing control to a
on destroying itself, by achieving a new wave of functionalism through a formless lens.









intent
THE MANIFESTO
Ifelt it was important to include in my work a manifesto; an unapologetically biassed response to today’s architecture that has suffered to the cost of control. It appropriately broaches the principles that I have examined over the duration of the course. Many manifestos arise from a background of high art, yet they have been commandeered by pop culture and politics, creating them as accessible writings for a mass audience. This dichotomy chimes perfectly with the principles of formlessness. Held as a topic for those studying the intricacies of fine art, yet a principle that is designed for use by all, holding nothing to the standards of ‘high’ or ‘low’, rather everything just is, and is a brief interlude to the chaos that will eventually dominate again. The manifesto itself is a conglomeration of past work, forming a provocation with an intentional unmediated tone. This is presented in a format that nods to the strong iconography of the boom of pop culture in the nineties, reflective of its intention for consumption by the masses, not attempting to reserve itself for a culture of high art.

Form and architecture are two words that are often synonymous with each other; one cannot be without the other. Architects are
creation and manifestation of form, grasping at any opportunity to exert the maximum control over every element of a design. This embodies the typical approach to design where the form is created as a whole and then filtered down through every element of the building, i.e. top down.

in its duty of enclosure and disclosure. The decline in significant meaning of form in architecture can be traced to the industrial revolution and the rise of the influence of technology that permeates every aspect of modern life,
so can the effect of climate change be accredited to this same period. On an intimate scale, the architecture that houses our daily lives has been reduced to a box of moderate security, lacking the art and beauty that conveys truly
Disclosure, where architecture denotes a higher power, which makes our lives
helped us make sense of the world around us. Historically, religion has dominated everyone’s daily lives, across cultures and countries, yet
obsessed with the manipulation,
Architecture is lacking fulfilment meaningful visible and meaningful,
today, in the face of scientific and technological progress atheism is on the rise. This should leave room for achievements in other fields. One of the greatest challenges facing almost all industries is that of climate change, and any architecture that is created today must be created with suitable environmental considerations. Although almost every new building must adhere to multiple
restrictions and guidelines for sustainable construction, these standards attempt to minimise the dam-
age done, rarely eliminating it and not contributing to the solution. This leaves architects to
pointlessly play with form.

Current design falls short of achieving meaningful form, whilst simultaneously proving to fail to prevent the increasingly apparent destruction of our world.
Form and architecture are two words that are often synonymous with each other; one cannot be without the other. Architects are obsessed with the manipulation, creation and manifestation of form, grasping at any opportunity to exert the maximum control over every element of a design. This embodies the typical approach to design where the form is created as a whole and then filtered down through every element of the building, i.e. top down. Architecture is lacking fulfilment in its duty of enclosure and disclosure. The decline in significant meaning of form in architecture can be traced to the industrial revolution and the rise of the influence of technology that permeates every aspect of modern life, so can the effect of climate change be accredited to this same period. On an intimate scale, the architecture that houses our daily lives has been reduced to a box of moderate security, lacking the art and beauty that conveys truly meaningful form. Disclosure, where architecture denotes a higher power, which makes our lives visible and meaningful, helped us make sense of the world around us. Historically, religion has dominated everyone’s daily lives, across cultures and countries, yet today, in the face of scientific and technological progress atheism is on the rise. This should leave room for achievements in other fields. One of the greatest challenges facing almost all industries is that of climate change, and any architecture that is created today must be created with suitable environmental considerations. Although almost every new building must adhere to multiple restrictions and guidelines for sustainable construction, these standards attempt to minimise the damage done, rarely eliminating it and not contributing to the solution. This leaves architects to pointlessly play with forms. Current design falls short of achieving meaningful form, whilst simultaneously proving to fail to prevent the increasingly apparent destruction of our world. Form and architecture are two words that are often synonymous with each other; one cannot be without the other. Architects are obsessed with the manipulation, creation and manifestation of form, grasping at any opportunity to exert the maximum control over every element of a design. This embodies the typical approach to design where the form is created as a whole and then filtered down through every element of the building, i.e. top down. Architecture is lacking fulfilment in its duty of enclosure and disclosure. The decline in significant meaning of form in architecture can be traced to the industrial revolution and the rise of the influence of technology that permeates every aspect of modern life, so can the effect of climate change be accredited to this same period. On an intimate scale, the architecture that houses our daily lives has been reduced to a box of moderate security, lacking the art and beauty that conveys truly meaningful form. Disclosure, where architecture denotes a higher power, which makes our lives visible and meaningful, helped us make sense of the world around us. Historically, religion has dominated everyone’s daily lives, across cultures and countries, yet today, in the face of scientific and technological progress atheism is on the rise. This should leave room for achievements in other fields. One of the greatest challenges facing almost all industries is that of climate change, and any architecture that is created today must be created with suitable environmental considerations. Although almost every new building must adhere to multiple restrictions and guidelines for sustainable construction, these standards attempt to minimise the damage done, rarely eliminating it and not contributing to the solution. This leaves architects to pointlessly play with forms. Current design falls short of achieving meaningful form, whilst simultaneously proving to fail to prevent the increasingly apparent destruction of our world. Form and architecture are two words that are often synonymous with each other; one cannot be without the other. Architects are obsessed with the manipulation, creation and manifestation of form, grasping at any opportunity to exert the maximum control over every element of a design. This embodies the typical approach to design where the form is created as a whole and then filtered down through every element of the building, i.e. top down. Architecture is lacking fulfilment in its duty of enclosure and disclosure. The decline in significant meaning of form in architecture can be traced to the industrial revolution and the rise of the influence of technology that permeates every aspect of modern life, so can the effect of climate change be accredited to this same period. On an intimate scale, the architecture that houses our daily lives has been reduced to a box of moderate security, lacking the art and beauty that conveys truly meaningful form. Disclosure, where architecture denotes a higher power, which makes our lives visible and meaningful, helped us make sense of the world around us. Historically, religion has dominated everyone’s daily lives, across cultures and countries, yet today, in the face of scientific and technological progress atheism is on the rise. This should leave room for achievements in other fields. One of the greatest challenges facing almost all industries is that of climate change, and any architecture that is created today must be created with suitable environmental considerations. Although almost every new building must adhere to multiple restrictions and guidelines for sustainable construction, these standards attempt to minimise the damage done, rarely eliminating it and not contributing to the solution. This leaves architects to pointlessly play with forms. Current design falls short of achieving meaningful form, whilst simultaneously proving to fail to prevent the increasingly apparent destruction of our world. Form and architecture are two words that are often synonymous with each other; one cannot be without the other. Architects are obsessed with the manipulation, creation and manifestation of form, grasping at any opportunity to exert the maximum control over every element of a design. This embodies the typical approach to design where the form is created as a whole and then filtered down through every element of the building, i.e. top down. Architecture is lacking fulfilment in its duty of enclosure and disclosure. The decline in significant meaning of form in architecture can be traced to the industrial revolution and the rise of the influence of technology that permeates every aspect of modern life, so can the effect of climate change be accredited to this same period. On an intimate scale, the architecture that houses our daily lives has been reduced to a box of moderate security, lacking the art and beauty that conveys truly meaningful form. Disclosure, where architecture denotes a higher power, which makes our lives visible and meaningful, helped us make sense of the world around us. Historically, religion has dominated everyone’s daily lives, across cultures and countries, yet today, in the face of scientific and technological progress atheism is on the rise. This should leave room for achievements in other fields. One of the greatest challenges facing almost all industries is that of climate change, and any architecture that is created today must be created with suitable environmental considerations. Although almost every new building must adhere to multiple restrictions and guidelines for sustainable construction, these standards attempt to minimise the damage done,
fulfilment meaningful form. meaningful,
Architects’ obsession with creating form sits directly at odds with the natural environment. The buildings we construct are a far cry from organic structures that naturally form, and the building materials that we construct with are forced into shapes and structures that they would never naturally create. The dichotomy set up between architecture and the environment is this; Architects are wrestling the elements from our environment into precisely considered forms that only appear to be in beautifully harmony with their surroundings. The reality is a brutal holocaust that has pushed us to the edge of total world collapse. If architecture as creation of meaningful form no longer serves its purpose, then we should liberate the obsession with form altogether, and reap the benefits that could be achieved through this approach. To achieve such a goal requires radical action. Architecture itself is synonymous with control over form, so to radicalise this practice we must consider the antithesis of form; the form-less.

L’informe / The Formless / formlessness / formless / anti-form / informal / de-form / informe.
‘L’informe’, a term introduced to the world by controversial philosophical intellectual George Bataille in 1929, who first wrote of l’informe with intention for its introduction to become a methodology to celebrate the debased humanity in all of us. He hoped to use The Formless “to bring things down in the world”. Bataille countered his peers' obsession with sublimity and aestheticism with L’informe, a key factor in understanding L’informe is that
THE FORMLESS IS AN OPERATION
yet this operation has yet to be harnessed in a functional way. When considering some of the key properties of formlessness; the prioritisation of function over form, its nature as a process, its disregard for aestheticism (although not without beauty), a disruptor - these are also reflected in some of the values of Functionalism. Le Corbusier “denigrated the use of ornament” preferring instead the use of “pure-form”. Both functionalism and formlessness have strongly aligned principles, yet the latter has rarely been explored in architecture. By changing the paradigm through which we approach architecture, we are able to relinquish previous expectations, allowing us to tackle projects anew.
DESTRUCTIVE







 Destruct adjective capable of destroying itself or the object, system, or installation containing it
Destruct adjective capable of destroying itself or the object, system, or installation containing it
Formlessness offers the opportunity to break down the obsession with shoots created from that process. When discussing The Formless, ed must first be removed. L’informe, allows each user to interpret or itarian, and seeks to bring all that is formal and high in the world down
noun // adjective
L’informe is always in a state of flux or change, in a loose sense, behaving as though own way. The Formless has shifted its meaning, away from being anti-form, but and allow for a bottom-up approach. The Formless within the confines of architectural

give form // to construct
find benefit in the antithesis of this, deconstructing form, disrupting order? reach. When viewing today’s world of architecture, Bataille would wish the lens of the formless, implementing technologies currently being discovered tectures, sitting in the intersection between computational and biological
The Formless can be
When applying it to architecture and the built environment, the question of centric priorities, disregarding what we esteem, existing both in and out of the as an enacter of the Formless; by taking form and breaking this down via formlessness from form. The process of formlessness to form and its return break this loop. We attempt to soften our interventions and mimic naturally
Formlessness offers the opportunity to break down the obsession with form, instead focussing on the process framework of what is accepted and expected must first be removed. L’informe, allows each user to interpret formal and high in the world down to an equal level of chaos and disorder. The Formless is at once noun // ‘alive’. This leaves room for each user of informe to take it up for use in their own way. The Formless has shifted functions over form and allow for a bottom-up approach. The Formless within the confines of architectural designate, find benefit in the antithesis of this, deconstructing form, disrupting order? Architecture was the closest wish for formlessness to take it. A revival of functionalism is due, through the lens of the formless, implementing tectures, sitting in the intersection between computational and biological sciences, art, architecture and design, and the built environment, the question of its application becomes philosophical. The Formless disrupts anthropocentric Fungi, or indeed any decomposer, can be assessed as an enacter of the Formless; by taking form and breaking form. The process of formlessness to form and its return to formlessness is present in all life cycles, yet our human ecosystems, but we are not acting fast nor dramatically enough Formlessness offers the opportunity to break that process. When discussing The Formless, the predetermined framework of what is accepted and expected long as it is disruptive, egalitarian, and seeks to bring all that is formal and high in the world down to an equal a state of flux or change, in a loose sense, behaving as though ‘alive’. This leaves room for each user of informe but rather anti-hierarchy, the reordering to prioritise other functions over form and allow for a bottom-up approach. modus operandi is to give form // to construct // to designate, find benefit in the antithesis of this, deconstructing viewing today’s world of architecture, Bataille would wish for formlessness to take it. A revival of functionalism putational design, deep AI, emerging and living architectures, sitting in the intersection between computational found everywhere. When applying it to architecture and the built environment, the question of its application existing both in and out of the realms of human use. Fungi, or indeed any decomposer, can be assessed as an The Formless operation, creating formlessness from form. The process of formlessness to form and its return soften our interventions and mimic naturally occurring ecosystems, but we are not acting fast nor dramatically on the process of making and the offshoots created from that process. When discussing The Formless, the predetermined user to interpret or implement it in the way they see fit, as long as it is disruptive, egalitarian, and seeks to bring at once noun // adjective // verb. L’informe are always in a state of flux or change, in a loose sense, behaving Formless has shifted its meaning, away from being anti-form, but rather anti-hierarchy, the reordering to prioritise architectural practices is radical; why would a designer, whose modus operandi is to give form // to construct was the closest to sublimity that humankind could reach. When viewing today’s world of architecture, Bataille implementing technologies currently being discovered in computational design, deep AI, emerging and living and design, societal and political studies. The Formless can be found everywhere. When applying it to architecture disrupts anthropocentric priorities, disregarding what we esteem, existing both in and out of the realms of human and breaking this down via a variety of processes, they are using The Formless operation, creating formlessness yet our human interventions break this loop. We attempt to soften our interventions and mimic naturally occurring ty to break down the obsession with form, instead focussing on the process of making and the offshoots created and expected must first be removed. L’informe, allows each user to interpret or implement it in the way they down to an equal level of chaos and disorder. The Formless is at once noun // adjective // verb. L’informe each user of informe to take it up for use in their own way. The Formless has shifted its meaning, away from for a bottom-up approach. The Formless within the confines of architectural practices is radical; why would tithesis of this, deconstructing form, disrupting order? Architecture was the closest to sublimity that humankind it. A revival of functionalism is due, through the lens of the formless, implementing technologies currently section between computational and biological sciences, art, architecture and design, societal and political studies. the question of its application becomes philosophical. The Formless disrupts anthropocentric priorities, disregarding composer, can be assessed as an enacter of the Formless; by taking form and breaking this down via a variety formlessness to form and its return to formlessness is present in all life cycles, yet our human interventions are not acting fast nor dramatically enough. Formlessness offers the opportunity to break down the obsession discussing The Formless, the predetermined framework of what is accepted and expected must first be removed. tive, egalitarian, and seeks to bring all that is formal and high in the world down to an equal level of chaos change, in a loose sense, behaving as though ‘alive’. This leaves room for each user of informe to take it up ti-hierarchy, the reordering to prioritise other functions over form and allow for a bottom-up approach. The operandi is to give form // to construct // to designate, find benefit in the antithesis of this, deconstructing ing today’s world of architecture, Bataille would wish for formlessness to take it. A revival of functionalism tional design, deep AI, emerging and living architectures, sitting in the intersection between computational and everywhere. When applying it to architecture and the built environment, the question of its application becomes both in and out of the realms of human use. Fungi, or indeed any decomposer, can be assessed as an enacter Formless operation, creating formlessness from form. The process of formlessness to form and its return to
with form, instead focussing on the process of making and the offFormless, the predetermined framework of what is accepted and expectimplement it in the way they see fit, as long as it is disruptive, egaldown to an equal level of chaos and disorder. The Formless is at once
adjective // verb
though ‘alive’. This leaves room for each user of informe to take it up for use in their but rather anti-hierarchy, the reordering to prioritise other functions over form architectural practices is radical; why would a designer, whose modus operandi is to
process of making and the offshoots created from that process. When discussing The Formless, the predetermined interpret or implement it in the way they see fit, as long as it is disruptive, egalitarian, and seeks to bring all that is // adjective // verb. L’informe are always in a state of flux or change, in a loose sense, behaving as though shifted its meaning, away from being anti-form, but rather anti-hierarchy, the reordering to prioritise other architectural practices is radical; why would a designer, whose modus operandi is to give form // to construct // to closest to sublimity that humankind could reach. When viewing today’s world of architecture, Bataille would implementing technologies currently being discovered in computational design, deep AI, emerging and living archidesign, societal and political studies. The Formless can be found everywhere. When applying it to architecture anthropocentric priorities, disregarding what we esteem, existing both in and out of the realms of human use. breaking this down via a variety of processes, they are using The Formless operation, creating formlessness from human interventions break this loop. We attempt to soften our interventions and mimic naturally occurring break down the obsession with form, instead focussing on the process of making and the offshoots created from expected must first be removed. L’informe, allows each user to interpret or implement it in the way they see fit, as equal level of chaos and disorder. The Formless is at once noun // adjective // verb. L’informe are always in informe to take it up for use in their own way. The Formless has shifted its meaning, away from being anti-form, approach. The Formless within the confines of architectural practices is radical; why would a designer, whose deconstructing form, disrupting order? Architecture was the closest to sublimity that humankind could reach. When functionalism is due, through the lens of the formless, implementing technologies currently being discovered in comcomputational and biological sciences, art, architecture and design, societal and political studies. The Formless can be application becomes philosophical. The Formless disrupts anthropocentric priorities, disregarding what we esteem, an enacter of the Formless; by taking form and breaking this down via a variety of processes, they are using return to formlessness is present in all life cycles, yet our human interventions break this loop. We attempt to dramatically enough. Formlessness offers the opportunity to break down the obsession with form, instead focussing predetermined framework of what is accepted and expected must first be removed. L’informe, allows each bring all that is formal and high in the world down to an equal level of chaos and disorder. The Formless is behaving as though ‘alive’. This leaves room for each user of informe to take it up for use in their own way. The prioritise other functions over form and allow for a bottom-up approach. The Formless within the confines of construct // to designate, find benefit in the antithesis of this, deconstructing form, disrupting order? Architecture
construct // to designate,
order? Architecture was the closest to sublimity that humankind could wish for formlessness to take it. A revival of functionalism is due, through discovered in computational design, deep AI, emerging and living archibiological sciences, art, architecture and design, societal and political studies.
be found everywhere.
of its application becomes philosophical. The Formless disrupts anthropothe realms of human use. Fungi, or indeed any decomposer, can be assessed via a variety of processes, they are using The Formless operation, creating return to formlessness is present in all life cycles, yet our human interventions naturally occurring ecosystems, but we are not acting fast nor dramatically enough.
PERVASIVE
Bataille would wish for formlessness to take it. A revival of functionalism is due, through the lens of the formless, living architectures, sitting in the intersection between computational and biological sciences, art, architecture architecture and the built environment, the question of its application becomes philosophical. The Formless human use. Fungi, or indeed any decomposer, can be assessed as an enacter of the Formless; by taking form formlessness from form. The process of formlessness to form and its return to formlessness is present in all life cycles, occurring ecosystems, but we are not acting fast nor dramatically enough. Formlessness offers the opportunicreated from that process. When discussing The Formless, the predetermined framework of what is accepted they see fit, as long as it is disruptive, egalitarian, and seeks to bring all that is formal and high in the world L’informe are always in a state of flux or change, in a loose sense, behaving as though ‘alive’. This leaves room for from being anti-form, but rather anti-hierarchy, the reordering to prioritise other functions over form and allow would a designer, whose modus operandi is to give form // to construct // to designate, find benefit in the anhumankind could reach. When viewing today’s world of architecture, Bataille would wish for formlessness to take being discovered in computational design, deep AI, emerging and living architectures, sitting in the interstudies. The Formless can be found everywhere. When applying it to architecture and the built environment, disregarding what we esteem, existing both in and out of the realms of human use. Fungi, or indeed any devariety of processes, they are using The Formless operation, creating formlessness from form. The process of break this loop. We attempt to soften our interventions and mimic naturally occurring ecosystems, but we obsession with form, instead focussing on the process of making and the offshoots created from that process. When removed. L’informe, allows each user to interpret or implement it in the way they see fit, as long as it is disrupand disorder. The Formless is at once noun // adjective // verb. L’informe are always in a state of flux or up for use in their own way. The Formless has shifted its meaning, away from being anti-form, but rather anThe Formless within the confines of architectural practices is radical; why would a designer, whose modus form, disrupting order? Architecture was the closest to sublimity that humankind could reach. When viewis due, through the lens of the formless, implementing technologies currently being discovered in computaand biological sciences, art, architecture and design, societal and political studies. The Formless can be found becomes philosophical. The Formless disrupts anthropocentric priorities, disregarding what we esteem, existing enacter of the Formless; by taking form and breaking this down via a variety of processes, they are using The to formlessness is present in all life cycles, yet our human interventions break this loop. We attempt to soften

IT IS TIME FOR MORE RADICAL ACTION TO BE TAKEN.
We must turn away from our human-centric perspective to accommodate the non-human. To radically change our approach to design, we must destroy the top-down approach to creation, where the architect or designer relies on ego and presumption of knowledge of others to form a suitable habitat. Instead, by decentralising the self, and in extension, all that is human-centric, we create an alternative radical worldview which views all, both human and non-human, living or object, as equal. Our anthropocentric viewpoint is the cause of the climate disruption, our humanistic egos blinding us to the damage our technological advancements can cause. Increasing numbers of creators have begun to explore a new approach of working from the bottom up, by way of biological designs with organic forms that respond to their environment and thereby are allowed to shape themselves. The Wood Wide Web, is a mycelial network that spans the entire globe, linking all plants and ecosystems and constantly transmitting data through its entangled roots. Fungi does not act altruistically, rather playing God, deciding which plant life to support in a ‘take now’ - provided it will ‘pay later’ trade off. With advancements in bio-mimicry and bio-integration, and the comparatively recent discovery of this global mycelial network, imagine the human harnessing of this network, creating growing cities that respond to future changes in their environment via an entangled web of subsurface network sensors; a human ecosystem in harmony with the organic. Computational design and nanotechnologies combined with formulae time-tested by Mother Nature are creating new modes of design; biomimicry, emergent and living architectures. Some fields of design are heading in a way that hybridises these approaches; as technology develops, strides in computational and


IT IS TIME FOR MORE RADICAL ACTION TO BE TAKEN.
adaptive design are being made, whilst the approach towards living architectures and bottom-up design also is being explored. The concept of self-healing buildings feels more within reach than ever before, yet this technology is not widely available and does not extend to the free growth of dwellings as conceptualised in fiction. These are the fields that could radicalise our architectures into free-forming living cities. This would prioritise the functionality of a city over the form that it takes, whilst uplifting environmental concerns to the same level as societal equity and the economy. Actively participating in the biosphere.
THE PERFECT CITY: Social Equity, Economic success, and Environmental consideration.


THE FORMLESS CITY: exists within our existing cities. is unplanned, sprawling, growing unchecked, tumultuously unbound. A living urban sprawl. Unintentional wastelands. A celebration of chaos. When L’informe is used as a paradigm through which to explore all these structures, one is no more architecturally significant than the other. Favelas and slums exemplify creation stemming from a need.








mutate



verb change in form or nature.
mutate verb change in form or nature.
MUTATE

mutate verb change in form or nature.
mutate verb change in form or nature.
mutate verb change in form or nature.
mutate verb change in form or nature.
mutate verb change in form or nature.
mutate verb change in form or nature.
mutate verb change in form or nature.


MANIFESTO
When making the manifesto, I had in mind dissemination of its philosophies to a wider audience. To achieve this, it needed to be made from readily available material that could quickly be assembled to make large quantities, as well as have digital layouts that were eye-catching and could be easily integrated into magazines and other media. To achieve this, I created both digital and physical versions of the manifesto, in a pop culture inspired aesthetic. The physical copies are made from 3 A4 sheets, folded in half, the front cover black and white printed on coloured paper, then sewn together with a simple stitch. The text follows a more ‘formless’ layout, with grammar and formatting being adjusted as needed to suit the text’s contents. The aesthetic is at once a nod to pop culture, and aimed at consumption of the mass media, whilst also holding an almost ironic take on its subject. The free flowing forms of the text are an example of the ‘pointlessly playing with forms’ that is critiqued in the text, at once highlighting and buying into this obsession with aestheticism. I experimented with a variety of paper types for the cover, settling on this final one due to its inability to fully absorb the ink, resulting in the reader’s hands becoming muddied with the pigment that forms the contents of the manifesto itself. Each reading gradually reduces the manifesto, and the reader literally takes a part of the text away with them.



& 158
&
The creation of the manifesto forms the final part of the work produced for the MA Interior and Spatial Design course, yet it is not the end of this body of research. Over the duration of the course I have found greater depths of knowledge on my chosen subject, yet I finish the course with more questions and experimentation needed to find resolution (if any exists) on The Formless’ use value. The conference and exhibition represent the next step in these explorations; dissemination. This is the area that I feel needs more development within my work, and will be further explored during future research. The filming of the Mutative study in particular showed a hint of a path for this; the involvement of the public and interest they demonstrated during this experiment was far beyond my expectations. I hope that the conference and exhibition can further this interaction from the public with The Formless, and the observations and records I plan to make at these events will form a guidebook for my future plans in taking this research into a more public realm.



END OF UNIT 3
Please see separate document for the Reseach Record.






























 Foster, E. and Watson, R. (2008) Blood on Paper. London: Ivory Press.
Drucker, J. (1994) The Century of Artists’ Books. 2nd ed. New York: Granary Books Inc, p.181.
Foster, E. and Watson, R. (2008) Blood on Paper. London: Ivory Press.
Drucker, J. (1994) The Century of Artists’ Books. 2nd ed. New York: Granary Books Inc, p.181.



















 Cracks showing through the white tile
Cigarette butt amidst a ecological reserve
Parts of the city, part of the beach. Greenwich
Cracks showing through the white tile
Cigarette butt amidst a ecological reserve
Parts of the city, part of the beach. Greenwich





























































 London Underground’s Stockwell Station, tube platform wall
Wall in Battersea Arts Centre, showing fire damage & construction traces
Ex-Public analysis & sanitary inspectors office, Battersea
London Underground’s Stockwell Station, tube platform wall
Wall in Battersea Arts Centre, showing fire damage & construction traces
Ex-Public analysis & sanitary inspectors office, Battersea













 Table set up on day of filming, complete with signage, arts supplies and thank you snacks!
Table set up on day of filming, complete with signage, arts supplies and thank you snacks!



































 Vauxhall in the clouds
Overgrown door in Greenwich
Grimy concrete in Vauxhall
Vauxhall in the clouds
Overgrown door in Greenwich
Grimy concrete in Vauxhall



 Damp encroachment in multi-million pound new development, Vauxhall
Unexpected mushroom amidst concrete & steel in Battersea Arts Centre
Decades of grime in the London Underground
Damp encroachment in multi-million pound new development, Vauxhall
Unexpected mushroom amidst concrete & steel in Battersea Arts Centre
Decades of grime in the London Underground

foam board, pinned together, with plasticine detailing
Plaster casting section
foam board, pinned together, with plasticine detailing
Plaster casting section







 Fig 1. The rubber mould, unrefined the final model, is reminiscent ‘Armchair’ 1964, which I came book Formlose Mobel [Formless
Fig 1. The rubber mould, unrefined the final model, is reminiscent ‘Armchair’ 1964, which I came book Formlose Mobel [Formless




































































































































 Destruct adjective capable of destroying itself or the object, system, or installation containing it
Destruct adjective capable of destroying itself or the object, system, or installation containing it

























